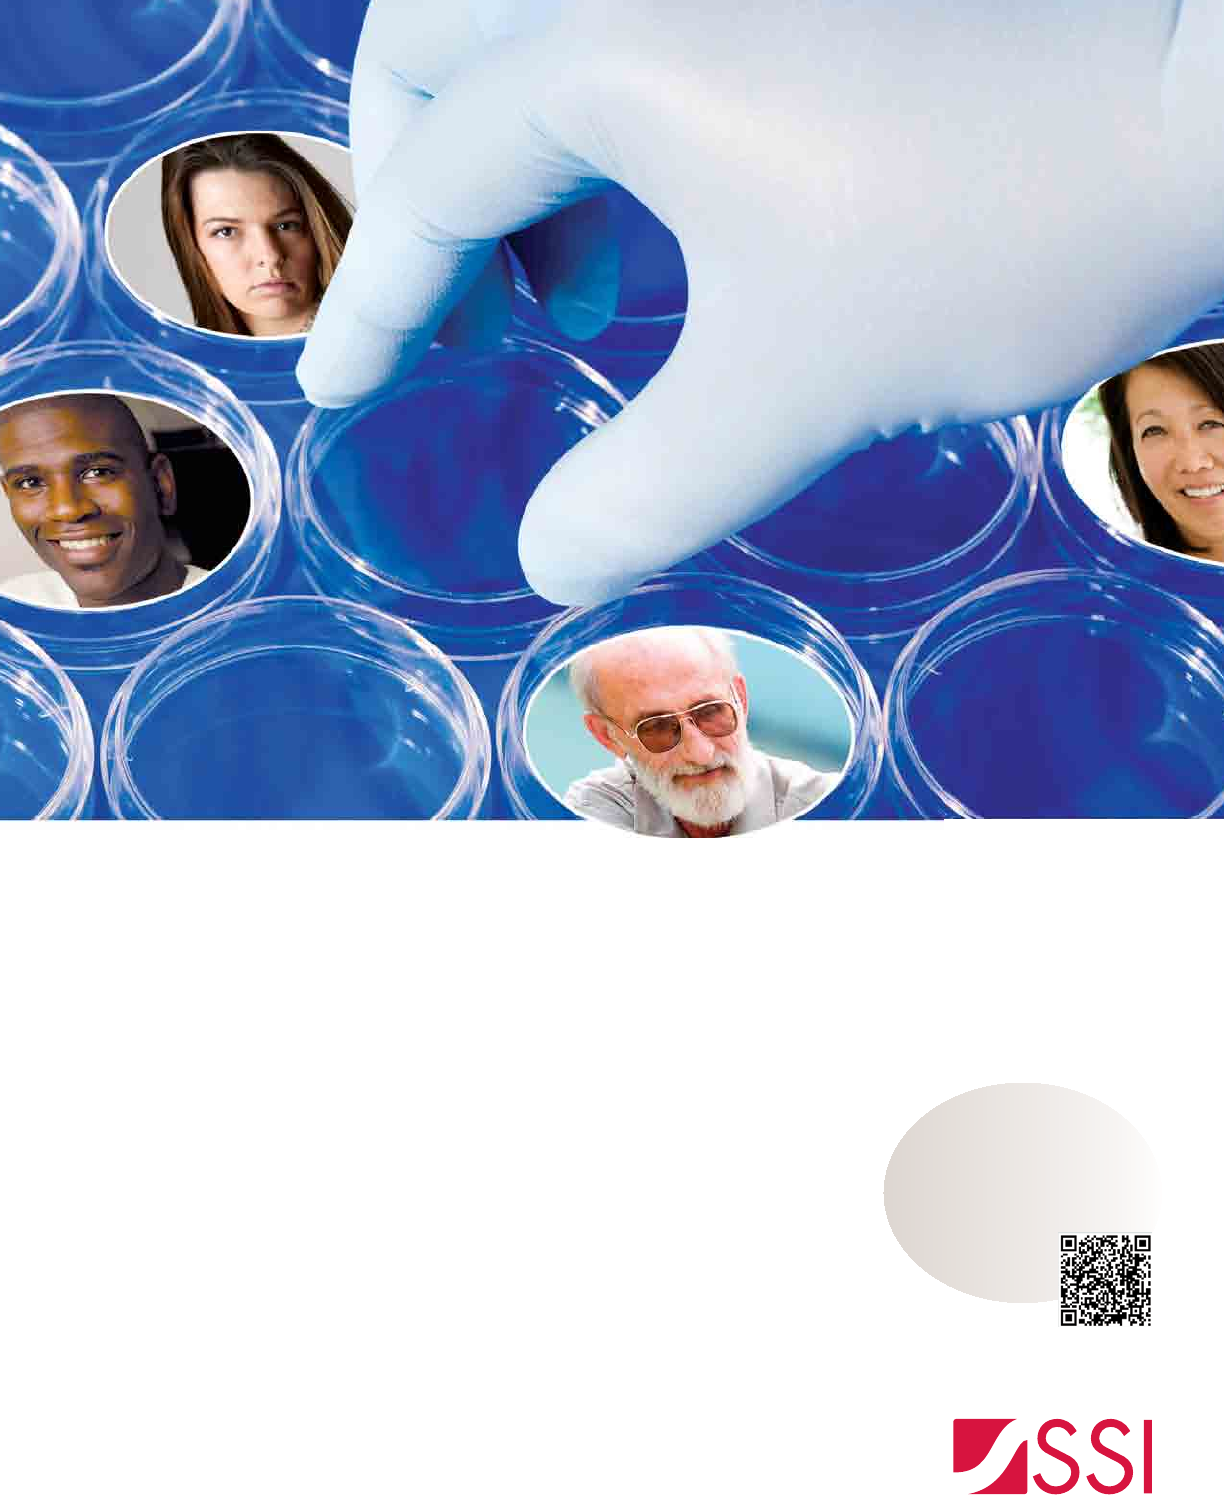

Evolution E 908 D DTCPM Sept 2011
User Manual: Evolution e 908 D
Open the PDF directly: View PDF
.
Page Count: 56

The Source For DTC Leaders
PERSPECTIVES
Vol. 10, No. 3 September 2011
PRST STD
U.S. Postage
PAID
Permit #108
Lebanon Junction
KY 40150
DTC PERSPECTIVES, INC.
110 Fairview Avenue, Suite 4
Verona, NJ 07044
CHANGE SERVICE
REQUESTED
Branded vs. Unbranded:
Evaluating Tactics to
Reach Digital Consumers
Rx Non-Adherence:
The Silent Epidemic
Find Digital Consumers
In a Sea of Mass Media
Reinvent DTC Marketing
To Meet Demand in an
Anywhere Health World
In This Issue
Nami Choe
Partner, Senior Director,
Consulting with Ogilvy
Healthworld
Bruce Rooke
Chief Creative Officer at
GSW Worldwide
Marketers have the opportunity to modernize DTC,
improving both campaign ROI and consumer reach

67 million readers • 43.4 million uniques 36 million readers • 6.2 million uniques 3.9 million uniques
yesterday
an apple a day is so
PARADE offers Americans practical steps for better living with
a dose of wellness, nutrition, beauty and medical news.
mediakit.parade.com Source: GfK MRI Fall 2010/Spring 2011; Dash is a publisher-defi ned prototype; comScore,
July 2011 (Parade Partners [E], DashRecipes [E], Parade Health [E])

Editor’s Desk ................................................................................................................4
DTC in Brief ..............................................................................................................6, 8
Spending Review ......................................................................................................10
Branded vs. Undbranded Digital Tactics: Reaching and Converting
Relevant Consumers .................................................................................................12
A series from Crossix RxMarketMetrics
Optimizing ROI through Integrated Marketing ..................................................17
Nami Choe, partner, senior director, consulting with Ogilvy Healthworld
It’s Time ‘DTC’ Stood for Something Else ............................................................20
Bruce Rooke, chief creative officer at GSW Worldwide
Medication Non-Adherence: The Health Care Industry’s Silent Epidemic .....22
Todd Steffes, vice president at FICO
Finding Digital Consumers in a Sea of Mass Media ...........................................26
Doug Zabor, executive vice president, and Qi Jiang, vice president of marketing science,
with Phoenix Marketing International
Memo to Digital Pharma Marketers: Don’t Overlook Viable
Content Sources ........................................................................................................32
Tanayia Washington, insights & analytics manager at CONTEXTWEB
What a Wonderful World it Would Be: Developing Relationship
Marketing Programs .................................................................................................36
Louis Winokur, director of analytics at DKI
Anywhere Health: Reinventing Healthcare Marketing in a
Connected World ......................................................................................................41
Jim Walker, director of emerging trends at Cadient Group
Promises and Perils: The Social Stock Market .....................................................44
Jane Chin, Ph.D., author, online authority & former pharma R&D/medical affairs
Marketing and Media Movers ................................................................................48
An update on DTC personnel and company changes within the industry
Contributors’ Page ...................................................................................................49
A closer look at the contributors to this issue of DTC Perspectives
Advertiser Index and Resource Center .................................................................49
Eye on the Hill: The Debt Ceiling is Just the Tip of the Iceberg ......................50
Jim Davidson reports on what to expect in the coming year from Washington
Perspectives on Books: Never Say Die: The Myth and Marketing of
The New Old Age .....................................................................................................52
Reviewed by Robert Ehrlich of DTC Perspectives, Inc.
DTC Perspectives Editorial: The Uncertainty of Healthcare Continues ..........54
Viable Content
Sources
32
Miss an issue, or want to order one from our archives?
Please visit our website www.dtcperspectives.com to view recent
issues of DTC Perspectives magazine, or call Debra Sander at
(973) 973-239-2051 to purchase previous issues.
PERSPECTIVES
September 2011 Vol. 10, No. 3
DTC Perspectives • September 2011 | 3
44
Social
Stock
Market
Relationship
Marketing
36

DTC Perspectives is Published Quarterly By:
DTC Perspectives, Inc.
110 Fairview Avenue, Suite 4
Verona, NJ 07044
Phone # 1-973-239-2051
Postmaster: Please send address changes to the above.
FREE to Qualified Industry Subscribers in the U.S.
Apply online at www.dtcperspectives.com.
Rates for International and Non-Industry
Subscribers:
$72 Per (1 Year) in the U.S.
$96 (1 Year) Outside of U.S.
Back Issues $10 in U.S.
$30 in All Other Countries
©2011 DTC Perspectives, Inc. All rights reserved.
No part of this publication may be reproduced in
any form unless given permission by the publisher.
Good Signs Ahead
A
fter periods of decline, DTC spending appears to be rebounding in the
first half of 2011, reaching $2.16 billion. Data from The Nielsen Com-
pany shows that to be a healthy increase over the prior year, up 7.6
percent. While several big name brands will be going off patent in the next few
years (including Lipitor, Plavix and Cymbalta), DTC Perspectives believes that
spending by new brands entering the market will counter such losses. Thus,
DTC levels will likely grow once again.
Marketers today understand how crucial DTC can be to a brand’s success;
consumers expect brands to be involved with the conversation. With new chan-
nels and methods for reaching and engaging consumers continually emerging,
marketers are embarking upon some very exciting times. DTC marketing is on
the cusp of an evolution that will break the current standards for communicat-
ing with patients. As Bruce Rooke, chief creative officer with GSW Worldwide,
discusses in his article, “DTC is due for some big innovation. … We have the
chance – and responsibility – to respond to the changing landscape with a whole
new vocabulary of action.” (Rooke’s article begins on page 20.)
In this era of constant change, marketers have the opportunity to re-invent
how they promote their brand – from a campaign’s creative and messaging
to how the brand engages with consumers to determining the optimal media
mix. However, improvements made to DTC campaigns would be fruitless if
they were not properly measured and appropriately adjusted when needed. As
advancements in analytics also develop, marketers can more accurately evalu-
ate campaigns and channels to optimize ROI. “Marketers are continuing to
unlock data analytics’ potential in optimizing investment real-time and in a
more targeted way,” detailed Nami Choe, partner, senior director, consulting
with Ogilvy Healthworld. Choe’s article (beginning on page 17) explains “as
we look to the future, with data becoming more available and tracking more
sophisticated, there are opportunities for marketers to understand the impact
of” their marketing efforts.
Progressing to the next level
With the plethora of opportunities created, jumping into the new frontier of
DTC marketing can seem like a daunting undertaking. However, our industry
must push forward to remain relevant and set new benchmarks for DTC. It is
with this goal that we have designed our upcoming fall conference, Marketing to
the Digital Consumer: Pharma Best Practices Present and Future. We hope that you
will join us Oct. 12-13, learning how you can improve current campaigns and
plan for upcoming initiatives in the future marketplace. We will also be induct-
ing our 2011 Hall of Fame class, featuring progressive industry members: Mark
Bard of the Digital Health Coalition, Bill Drummy of Heartbeat Ideas, Joan
Mikardos of Sanofi-Aventis, and Nancy Phelan of Pfizer.
PERSPECTIVES
Robert Ehrlich
Chairman and CEO
DTC Perspectives, Inc.
Christine Franklin
VP, Marketing and Sales
Jennifer Haug
Editor / Design Coordinator
Matt Yavorski
Sales Associate
Molly Diemel
Marketing and Production
Associate
Debra Sander
Office Coordinator
Scott Ehrlich
President
MDPA Division
Amanda Ehrlich
Director, Publishing
MDPA Division
Debra Rennert
Creative Director
James Ticchio
Art Director
Direct Media Advertising
Jennifer Haug
Sincerely,
4 | DTC Perspectives • September 2011

beaconhc.com
At Beacon, it’s all about you...
■ Your brand: we’ll listen to what you have to say
■ Your business: we’ll understand, because we’ve
been there too…in professional, managed markets,
DTC, oncology, and interactive
■ Your budget: we’ll be transparent and avoid surprises
■ Your success: our experienced professionals are ready
to focus on you
Call Adrienne Lee at 908.781.2600 and tell her what
Beacon can do for you or check out our Web site.
It’s all about you.
We have a thing
for ears…
AP-9009 BEACON AD_DTCPersp_2-2011.indd 1 2/25/11 11:20 AM

IN BRIEF
Facebook Policy Change in Effect,
Some Pharmas Shut Down Pages
As Facebook’s policy change requiring the comments feature
to be enabled on most pages went into effect mid-August, some
pharmaceutical companies have decided to close out their pages.
According to a Washington Post report, companies are concerned
with what the open-commenting policy could lead to. Combining
a lack of FDA guidance on social media best practices with con-
cerns about adverse event reporting (AER) and off-label claims,
companies have had to choose between shutting down their pages
or establishing a plan for continual monitoring of Wall comments.
With many of the companies having joined Facebook within the last year and half, the Post explained that some have
chosen to closely monitor their pages themselves or via a third party rather than turning away. Pfizer and Sanofi each told
the newspaper that they plan to keep their pages online, noting that such engagement and feedback they have garnered
outweighs concerns. While currently uncertain of its potential impact, Amgen and Novo Nordisk have decided to simply
“monitor the situation.”
Meanwhile, AstraZeneca, maker of depression treatment Seroquel XR, opted to close its “Take on Depression” page;
Johnson & Johnson also followed suit by shutting down four of its pages – two devoted to ADHD, as well as rheumatoid
arthritis and psoriasis. Johnson & Johnson manufacturers the respective treatments of Concerta, Simponi and Remicade,
and Stelara. As with all pages, marketers can remove any posted comment from their Wall. Pages devoted to Rx products
can still disable the commenting feature entirely.
Rep. Quayle Meets with WKPS Executives
To Discuss Delivery of Health Information
Congressman Ben Quayle (R-Ariz.) met with executives from Wolters Kluwer Pharma Solutions (WKPS) in late
August to discuss the current state of health information in America. The first-term Congressman and son of former
vice president Dan Quayle is eager to learn more about how industry can improve the delivery of health information
and safety. He was treated to a presentation about health information technology by WKPS executives, including joint
presidents Bob Jansen and Michelle Woker, members of the healthcare analytics team, including Cathy Betz, vice pres-
ident of government affairs, and the company’s Arizona lobbyists,
TriAdvocates.
“One of the things we shared with Congressman Quayle is
our conviction that preserving good access to health information
is vitally important to America’s health as a country,” said Bob
Jansen, president of Wolters Kluwer Pharma Solutions’ healthcare
analytics business in a news release. “The Congressman also shares
the conviction that transparent and actionable health information is
in the best interest of public health.”
WKPS is a leading provider of scientific information and ana-
lytics to pharma/healthcare professionals. While the firm is cur-
rently seeking a buyer, they plan to continue as a leader in the
health information space.
Rep. Ben Quayle (center) met with WKPS’ Bob Jansen, president
and chief commercial officer, and Michelle Woker, president and
chief operating officer, to discuss improvements of today’s delivery
of health information.
6 | DTC Perspectives • September 2011
SSI Brings Its 34 Years of Sampling Leadership to Healthcare, with the Broad Reach
and Precise Targeting to Optimize Your Patient, Caregiver and Physician Research!
Your market research drives your most critical business decisions. And the quality of your research depends
on the quality of your sample. That’s why companies around the globe, including 48 of the top 50 market
research fi rms, trust their most important projects to SSI. Now, SSI is bringing the scientifi c rigor that made us
the world’s sampling leader for 34 years to healthcare, with our new access to patients, caregivers, physicians
and allied health professionals. You benefi t from:
• Wide reach across key therapeutic categories, including metabolic
syndrome, respiratory ailments, mental health, lifestyle treatments and more
• Real-time dynamic profi ling to identify and engage precise segments
• Advanced quality processes—from digital fi ngerprinting to third-party
database matches—to ensure data integrity
• A full range of online and offl ine modes—Web, phone, mobile and mixed
access—to optimize reach
You wouldn’t build your products on anything less than solid science—and neither would we. Experience
the difference sampling science can make in the accuracy of your research. Contact Chris DeAngelis at
203-567-7220 or Chris_DeAngelis@surveysampling.com.
info@surveysampling.com | surveysampling.com
Pure Science
Now…the Science of Sampling
Meets the Science of Medicine
Register FREE for
SSI’s New Webinar—
Mapping the Hi-Tech
Consumer
—at
surveysampling.com/hitech
or scan here.

IN BRIEF
Botox Receives FDA Approval
For Seventh Medical Treatment
The FDA has granted Allergan’s Botox approval for the treatment of “urinary inconti-
nence in people with neurologic conditions such as spinal cord injury and multiple sclerosis
who have overactivity of the bladder,” the agency announced in a news release. As
reported by The New York Times’ blogger, Duff Wilson, this is the seventh medical
condition for which Botox has been authorized to treat since premiering in 2002 as a
cosmetic treatment.
According to the FDA, the Botox injection will relax the bladder, resulting in an
“increase in its storage capacity and a decrease in urinary incontinence” for up to 10
months. Company spokeswoman, Caroline Van Hove, told the Times that Botox has
been studied for more than 100 medical conditions, referring to the drug as “a pipe-
line in a vial.” She added that Allergan is also seeking approval for idiopathic urinary
incontinence.
Other Botox indications include treatment for: hyperhidrosis, chronic migraine headaches, and certain muscle stiffness
and contractions. Global sales for the multi-use drug were approximately $1.5 billion in 2010. Seamus Fernandez, an ana-
lyst with Leerink Swann, predicts sales in the region of $40 million for the current bladder treatment and $210 million for
the broader label by 2017, according to a Reuters report.
Lilly Diabetes Collaborates on
Type I and II Awareness Efforts
To further diabetes awareness and support, Eli Lilly has partnered with the American Diabetes Association (ADA) and
award-winning actor/comedian Anthony Anderson on a type 2 diabetes effort; and Disney and Denise Jonas, mother of
Nick from the Jonas Brothers, for a type 1 diabetes initiative. (Nick Jonas has worked with Bayer Diabetes Care in the
fight against juvenile diabetes.)
Continuing its successful Fearless African-American Connected and Empowered (F.A.C.E.) Diabetes campaign, Eli
Lilly teamed with Anthony Anderson on their most recent effort. Anderson, a paid spokesperson, travelled with the phar-
maceutical giant in events “around the United States to raise awareness of the type 2 diabetes epidemic among African
Americans, a population disproportionately affected by the disease. In fact, according to the [ADA], African Americans are
1.8 times more likely to have diabetes than non-Hispanic whites,” Eli Lilly & Co. explained in a news release. The most
recent event took the “Law & Order” actor to the 14th annual Victory Over Diabetes, a free event hosted by the ADA in
Atlanta.
Moving over to Lilly Diabetes’ type 1 efforts, this campaign will target parents and caregivers whose loved ones have
been diagnosed with the condition. Hosted under the Parenting section on Disney’s Family.com website, visitors can
view informational videos and articles, and connect with other caregivers. Disney Publishing Worldwide will also pro-
vide doctor’s offices with custom children’s books geared to various ages and life-stages with diabetes. Additionally, the
partnership has created the Once Upon a Time contest featuring Denise Jonas. Families
can submit a story, poem or essay about their child’s experience with type 1 diabetes.
Selected by an independent panel of judges, the winner will receive a family trip for four
to the 2012 Friends For Life, an annual international conference devoted to children with
the condition.
8 | DTC Perspectives • September 2011

PROVEN SALES LIFT
MEASURABLE ROI
TARGETED MEDIA
Patient-Centric Marketing via
Specialty Point-of-Care Networks
Awareness:
1 million patients are
watching each month
Compliance:
94% of patients are
purchasing products
immediately
Action and Acquisition:
51% of patients are
asking their HCP
PROVEN SALES LIFT
MEASURABLE ROI
TARGETED MEDIA
Patient-Centric Marketing via
Specialty Point-of-Care Networks
Awareness:
1 million patients are
watching each month
Compliance:
94% of patients are
purchasing products
immediately
Action and Acquisition:
51% of patients are
asking their HCP
PROVEN SALES LIFT
MEASURABLE ROI
TARGETED MEDIA
Patient-Centric Marketing via
Specialty Point-of-Care Networks
Awareness:
1 million patients are
watching each month
Compliance:
94% of patients are
purchasing products
immediately
Action and Acquisition:
51% of patients are
asking their HCP
Patient-Centric Marketing Via
Specialty Point-of-Care Networks
Awareness:
Millions of patients are
watching each month1
Action and
Acquisition:
51% of patients are
asking their HCP2
Compliance:
94% of patients are
purchasing products
immediately3
1. Monthly Affidavits, 2010. 2. Deibler Consulting, 2008. 3. Audits & Surveys Worldwide, 2001
ContextMedia owns and
operates a portfolio of the
largest condition-specific
in-office digital networks
For more information, contact:
Shradha Agarwal,
Chief Marketing Officer
312.239.6656
shradha.a@contextmediainc.com
✔ ROI Guarantee
✔ Proven Results
✔ State-of-the-art Technology
✔ Advanced Reporting
1115a-CM_DTC_Ad_7'11.indd 1 7/28/11 11:13 PM

REVIEW
DTC Spending Showing Healthy Signs of Growth at 7.6% in First Half
Five New Brands/Treatment Indications Rank among Top 20 Spenders
Brand Manufacturer 1H 2010 1H 2011 $ Change % Change
Lipitor Pfizer $141,059,869 $144,924,859 $3,864,990 2.7%
Cymbalta (Pain) Lilly USA $0 $72,541,275 $72,541,275 N/A
Uloric Takeda Pharmaceuticals $244,590 $72,269,377 $72,024,787 29447.2%
Cialis Lilly USA $93,285,343 $71,352,468 -$21,932,875 -23.5%
Celebrex Pfizer $0 $66,677,970 $66,677,970 N/A
Abilify Bristol-Myers/Otsuka America $71,729,538 $63,926,868 -$7,802,670 -10.9%
Seroquel XR AstraZeneca $0 $62,028,290 $62,028,290 N/A
Pristiq Pfizer $77,197,469 $61,367,844 -$15,829,625 -20.5%
Lyrica Pfizer $61,278,288 $59,598,520 -$1,679,768 -2.7%
Cymbalta (Depression) Lilly USA $84,570,291 $56,488,760 -$28,081,531 -33.2%
Viagra Pfizer $44,489,842 $55,443,355 $10,953,513 24.6%
Advair Diskus (Asthma) GlaxoSmithKline $80,361,827 $51,455,379 -$28,906,448 -36.0%
Plavix Sanofi-Aventis/Bristol-Myers $67,918,130 $50,100,266 -$17,817,864 -26.2%
Chantix Pfizer $63,458,544 $49,592,955 -$13,865,589 -21.8%
Enbrel Amgen/Pfizer $4,502,295 $48,351,033 $43,848,738 973.9%
Advair Diskus (COPD) GlaxoSmithKline $55,954,049 $46,280,597 -$9,673,452 -17.3%
Niaspan Abbott Laboratories $5,085,769 $42,912,129 $37,826,360 743.8%
Boniva Genentech/Roche $36,121,712 $42,671,928 $6,550,216 18.1%
Vimovo AstraZeneca $0 $40,800,076 $40,800,076 N/A
Beyaz Bayer HealthCare $0 $39,360,372 $39,360,372 N/A
Total Spending for Top 20 Brands $887,257,556 $1,198,144,321 $310,886,765 35.0%
Total Pharma Spending $2,010,966,227 $2,163,414,680 $152,448,453 7.6%
Media Type 1H 2010 1H 2011 $ Change % Change
65%
Television $1,345,251,695 $1,401,769,069 $56,517,374 4.2%
29%
Magazine $547,455,629 $624,932,017 $77,476,388 14.2%
5%
Newspaper $92,678,960 $117,297,547 $24,618,587 26.6%
1%
Radio $23,663,848 $18,468,477 -$5,195,371 -22.0%
0%
Outdoor $1,916,095 $947,570 -$968,525 -50.5%
Total Pharma
Spending
$2,010,966,227 $2,163,414,680 $152,448,453 7.6%
Source: The Nielsen Company for DTC Perspectives
Nielsen Monitor-Plus is the leader in innovative advertising information services and tracks advertising activity across 18 media types.
For more information, send an e-mail to Marisa Grimes at Marisa.Grimes@nielsen.com.
0%
1%
5%
29%
65%
Television Sees Slight Increase in DTC Promotions
Magazine Segment Gains Market Share
NOTE: Excludes
Internet Advertising
10 | DTC Perspectives • September 2011

His healthcare decisions are influenced by
much more than a visit to his physician.
While physician advice and
prescribing greatly influence
patients, it’s not just physicians
that impact patient behavior.
Patients’ treatment decisions
are also influenced by
information they learn from
other sources, including
patient education programs
and advertising.
By utilizing the most
comprehensive view of patient
behavior and characteristics –
both healthcare- and
consumer-related – SDI can
identify the best venues for
reaching patients and crafting
the most relevant messages.
SDI leads the industry in
providing empirical,
patient-level data to inform
and improve advertising
strategies. We provide insight
on patients’:
• Media preferences
• Advertisement exposure
• Behavior post-exposure
• Attributes and demographics
To learn more, please call
Melissa Leonhauser at
1-800-982-5613 or
visit:www.sdihealth.com/influence

12 | DTC Perspectives • September 2011
Branded Versus
Unbranded Digital Tactics
What to expect in reaching relevant
consumers and converting to brand
C
ampaign planning involves analyzing the tradeoffs
between marketing approaches. In pharmaceuticals,
these decisions grow more complex when choos-
ing not just between channels, but also between branded or
unbranded communications. Marketing decisions become
even murkier considering regulatory compliance requirements
and legal approvals – especially, though not exclusively, with
branded messages. Unbranded messages can often be under-
taken at a lower cost because of the less stringent fair balance
requirements. This results in messages that can be
conveyed in fewer pages, shorter television time,
or smaller display space.
Of course, an unbranded message is typically
not as powerful in driving direct conversion ben-
efit (new patient starts) to a brand. Branded mes-
sages drive the product ethos to patients while
unbranded messages serve to increase disease
awareness and education. While unbranded mes-
saging can grow the size of the market, branded
messaging is necessary to increase a brand’s share
of new patient starts.
The decision as to when and where to use
branded versus unbranded communication can
be challenging in the ever-evolving realm of
digital marketing. Cost considerations aside, one
would hypothesize that branded tactics executed
digitally would more effectively generate conver-
sion to a prescription while unbranded tactics
would hit a wider audience to raise disease or
category awareness and drive a qualified audi-
ence. A meta analysis of branded versus unbrand-
ed digital tactics supports this hypothesis and uncovers
actionable insights into when each should be used along the
continuum of prospect identification, consumer engagement
and conversion to brand use.
Benchmarking quality
Crossix RxMarketMetrics sheds light on performance dif-
ferences between branded and unbranded tactics using mean-
ingful norms that can help guide brand teams in their planning
efforts. RxMarketMetrics generates these market norms by
An examination of Rx-based benchmarks for branded and unbranded digital tactics demonstrates unique
advantages and disadvantages offered by each. Pharma marketers can leverage the strengths and mitigate
the weaknesses of branded and unbranded tactics by understanding which strategic goals each type of tactic
can best support.
Crossix RxMarketMetrics Series
Figure 1: Percentage of Audience Treating in Category
57% 58%
0%
20%
40%
60%
80%
Audience Treating in Category
Branded
Unbranded
% of Audience
Source: Crossix RxMarketMetricsTM March 2011.

DTC Perspectives • September 2011 | 13
BRANDED VS. UNBRANDED
aggregating hundreds of actual Rx matchback
analyses over a broad range of media tactics,
brands and therapeutic categories. RxMarketMet-
rics measures the quality of engaged consumers
through the metric Percentage of Audience Treating
in Category. Audience Treating in Category includes
both existing patients on a specific brand as well as
prospects treating with a competitive therapy. Per-
centage of Audience Treating in Category is a measure
of how well a tactic attracts a relevant audience
likely interested in a brand’s message and, thus,
likely to engage.
Audience vs. prospects
A comparison of quality of engaged audiences
between branded and unbranded tactics across
channels demonstrates meaningful differences in
Rx profile. The median branded tactic generates a
similar share of a qualified audience as the median
unbranded tactic. (See Figure 1.) However, by
drilling down and looking at only those not exist-
ing patients (candidates for conversion), further
insights emerge.
Analysis of the Percentage of Prospects Treating in
Category demonstrates that unbranded tactics drive more quali-
fied prospects than branded tactics. The median unbranded
tactic generates seven percentage points more qualified pros-
pects than the median branded tactic. The lower level gener-
ated from branded tactics is driven by the fact that branded
tactics often attract existing patients treating on the branded
Rx, whereas unbranded drives higher proportion of prospects.
(See Figure 2.)
Based on the median rates, unbranded tactics more effec-
tively drive qualified prospects than branded tactics. However,
this does not necessarily mean that the audience converts at the
same rate as branded. Despite generating a higher rate of Pros-
pects Treating in Category, typical unbranded audiences may not
start at the same point in their treatment decision-making pro-
cess as branded audiences, with implications on effectiveness of
further education and brand-specific messaging.
Branded vs. unbranded conversion
Percentage of Total Conversion Benefit (net of control) quantifies
the time to conversion to a brand Rx realized on a monthly
basis. An examination of two digital tactics, search and web-
site, demonstrates the differences in time to conversion
between audiences engaged with branded tactics and those
engaged with unbranded tactics. In addition to differences
between branded and unbranded tactics in time to conversion,
differences also emerge in absolute conversion rates as well as
the size and scalability of the engaged audience. Among the
top 20 percent of programs, branded tactics drive 1.2x higher
About Crossix RxMarketMetrics
Prescription drug information drawn from Crossix RxMarketMetrics™, market benchmarks for performance of patient
adherence and consumer marketing activities based on thousands of actual Rx analyses including more than 600 consumer
marketing tactics across a broad range of therapeutic categories.
Campaigns included in RxMarketMetrics aggregated for the chronic, lifestyle and specialty/biologic markets and derived
from actual anonymized and aggregated results of consumer marketing campaigns for dozens of leading pharmaceutical
brands ranging from direct response (DR) to general awareness and branding campaigns (GA), and multi-channel, from Web
to Print to TV.
Normative Rx-based measures include conversion rates and curves, retention rates and curves, and Rx patient profiles spe-
cific to the market, channel and tactic. Benchmarks are further broken down by campaign specifics, such as purpose, level of
branding, creative, offer type, response channel and fulfillment stream.
Figure 2: Percentage of Prospects Treating in Category
vs. Existing Patients
46%
11%
53%
5%
0%
20%
40%
60%
80%
Prospects Treating in Category Existing Patients
Branded Unbranded
% of Audience
Source: Crossix RxMarketMetricsTM March 2011.

14 | DTC Perspectives • September 2011
rates of conversion than unbranded tactics. Sometimes branded
communication elements follow unbranded campaigns, poten-
tially mitigating an even larger difference.
Looking at a six month horizon, we see that the benefit
from branded search shows more quickly with 45 percent of
benefit achieved in just the first month versus 38 percent for
unbranded. Unbranded search share of bene-
fit continues to track comparably with brand-
ed search through the six months, although
at a slightly lower level. (See Figure 3.) An
even larger first month variance appears
when examining branded and unbranded
websites.
Branded websites achieve nearly three-
fifths of the total conversion benefit in just
the first month. It takes unbranded websites
nearly four months to achieve the same share
of benefit – by which point branded websites
have realized over 90 percent of the ben-
efit. (See Figure 4.) A script-in-hand effect
can partially explain this rapid realization of
conversion through both search and branded
websites, wherein visitors to the branded site
have recently received their first Rx and then
proceed to research the product before visit-
ing the pharmacy.
Acting on this information
Brands and agencies typically view
unbranded tactics as a means of casting a
wide net to raise disease awareness, educate
potential patients and grow the size of the
market. RxMarketMetrics demonstrates that
unbranded tactics executed digitally can serve
as a powerful way to attract prospects treat-
ing in category. However, these individuals
convert more slowly and need further sup-
port by branded messages to continue to
move the potential customer from a prospect
to a patient. In considering unbranded cam-
paigns, the lower cost of media, the reduced
regulatory constraints in messaging, and the
broader appeal to higher volume of quali-
fied prospects (wider net) should be weighed
against slower time to conversion and lower
conversion than a similar branded campaign.
The product lifecycle and market share will
often play a major role in considering these
alternatives. Ongoing, granular Rx analysis
of tactics can inform on in-market campaign
performance in near real time.
This is a fourth installment of an ongoing series on Rx market metrics
of various consumer marketing activities. For more information, see the
Crossix RxMarketMetrics™ website (www.rxmarketmetrics.com),
from Crossix Solutions Inc., an Rx-based consumer analytics company
(www.crossix.com).
BRANDED VS. UNBRANDED
Figure 3: Percentage of Total Conversion Benefit – Search
0%
25%
50%
75%
100%
1 2 3 4 5 6 7 8 9
Unbranded
Branded
% of Total Conversion Benefit
Month
Source: Crossix RxMarketMetricsTM March 2011.
Figure 4: Percentage of Total Conversion Benefit – Website
0%
25%
50%
75%
100%
1 2 3 4 5 6 7 8 9
Unbranded Branded
Month
% of Total Conversion Benefit
Source: Crossix RxMarketMetricsTM March 2011.

Providing targeted data driven
solutions for consumer focused
health & lifestyle brands
Call:
Jim Curtis, Chief Revenue Offi cer
jcurtis@remedyhealthmedia.com
212-695-5581
your
remedy
we have
RHM_DTC_Sept_Ad_080111_FINAL.indd 1 8/1/11 10:01 AM

A DTC Perspectives Inc.
Conference
As technology provides exciting new possibilities, Digital DTC
Marketing must push forward, mitigating risks while maximiz-
ing potential gains. Learn how to improve current campaigns
while planning for future initiatives. Hear from 25-plus progres-
sive speakers streamlined over two days:
• Legislative issues you need to be aware of and how to respond
• Accurately evaluate ROI to optimize your digital DTC efforts
• Effective social media programs that secure med/legal approval
• Discover missing pieces in your social media engagement plan
• Improve health communications and brand adoption/loyalty
Marketing to the
Digital Consumer
Phone:
973-239-2051 ext. 221
Online:
www.dtcperspectives.com
under Conferences tab
REGISTER TODAY
Passes starting at $1,995
(includes full access to the conference, events and exhibit hall)
Pharma Best Practices Present and Future
Christopher D. Johnson,
Consumer Brand
Director, AstraZeneca
Todd Kolm
Director Emerging
Channel Strategy,
US Primary Care Consumer
Portfolio, Pfi zer Inc
Matt Giegerich
Chairman & CEO,
Ogilvy CommonHealth
Worldwide
Jane Chin, Ph.D.
Author, online authority
and formerly pharma
R&D/Medical Affairs
Mark Bard
Executive Director and
Co-Founder, Digital
Health Coalition
Raquel Krouse
Sr VP, Prophesee,
Initiative USA
Stu Klein
Interpublic Healthcare
Practice Lead
John Vieira
Senior Director, Marketing
Operations and Strategic
Services, Daiichi Sankyo, Inc.
With Expert Input and Analysis by
Conference Co-Chairs…
Visit www.dtcperspectives.com
for full agenda and details.
Join the
Conversation Now
#DTCDigital
October 12–13, 2011 • Crowne Plaza, Fairfi eld, NJ
Register Now to Hear from Digital Experts:

DTC Perspectives • September 2011 | 17
Optimal ROI is best achieved when the interactions between marketing channels and campaign tactics work
together to increase overall marketing effectiveness. Pharma marketers should focus on three key steps when
measuring integrated campaign ROI: audience type, channel mix, and timing.
by Nami Choe
C
onsumers’ preferences and modes of communication
are diversifying exponentially faster than most contem-
porary marketers can nimbly adapt. By the time mar-
keters collectively acknowledge and begin to understand a new
advent in the industry, another innovation emerges to trans-
form the landscape yet again. (Marketers were still attempt-
ing to unlock mobile’s potential when tablets and new social
media platforms like Foursquare marched into the forum.)
In these circumstances, particularly against the backdrop of
heightened economic pressures, the integrated marketing
approach has regained prominence in industry dialogue with
natural reason. Brands are seeking more structured frameworks
for determining the optimal marketing and media mix.
Marketers must be diligent and fastidious in
their measurement planning to avoid common
pitfalls that inadvertently compromise the
fundamentals of integrated marketing.
The rapidly increasing number of tactics in the media
toolbox yields a complex menu for marketers to select from,
boosting the demand for data-driven analyses and predictive
models to ensure that the final plan will derive the maximum
ROI possible. However, campaign measurement remains
relatively nascent with respect to cross-channel algorithms for
quantifying synergies generated from various media combina-
tions and investment scenarios. Marketers must be diligent and
fastidious in their measurement planning to avoid common
pitfalls that inadvertently compromise the fundamentals of
integrated marketing.
Frequent fluctuations and tightening of budget constraints
during the campaign development process have gener-
ated understandable hesitation to commit to marketing plans
without comprehending how each tactic will contribute to
bottom-line sales and ROI. Internal and agency analytics teams
often collaborate to model multiple investment scenarios to
compare the potential returns associated with various media
mixes.
The challenge with designing predictive models for inte-
grated marketing efforts, though, has been the lack of cross-
channel benchmarks to inform assumptions for lift and return.
Traditionally, third-party vendors specialized in the measure-
ment of a single medium, so most historical data points pertain
to a channel’s independent efficacy, regardless of its relation-
ship with other campaign elements in the consumer’s overall
experience with a brand. Research vendors are making sig-
nificant strides toward centralizing data to expand their breadth
of cross-channel measurement, but a solid and universally
accepted methodology has yet to be introduced. As a result,
the inputs and assumptions for predictive ROI models do not
always account for potential synergies derived from multiple
channels and their cadences.
Optimizing ROI
Through
Integrated
Marketing

18 | DTC Perspectives • September 2011
At the eventual step of minimizing costs to maximize the
ROI output, channels and touches thereby risk omission with-
out the model reflecting the opportunity from its relationship
with other media. In other words, the channels are evaluated,
mixed and matched as independent entities – contrary to the
underlying principles of integrated marketing. Rather than
wait for third-party vendors to release blinded benchmarks
to improve media mix assumptions, marketers should focus
on building their internal repository of cross-channel results
through robust measurement planning that truly reflects the
integration for which their plans strive.
Establish measurement plans
Commence measurement planning before creative
development to ensure that all tactics are tracked prop-
erly. Defining tracking requirements upfront ensures sufficient
time for creative partners and vendors to assist with maximiz-
ing visibility into campaign dynamics. Measurement is too
often an afterthought upon the program’s completion, when
it is too late to implement the appropriate tracking instruments
to address key questions.
The most challenging part of this process is agreeing upon
campaign and tactical objectives. Once key stakeholders are
in agreement, the measurement plan becomes less of a burden
and less time consuming on the analyst without going back
and forth with vendors and marketers. When approached with
discipline and structure, translating objectives into measure-
ment and optimization
plans can be an efficient
process that uncovers data
gaps, minimizes tactical
issues and ultimately keeps
all partners aligned with
marketing goals.
Measurement require-
ments should focus
on enabling tracking
consumer engagement
across multiple chan-
nels. While legal parameters
might limit the granularity
at which consumer activi-
ties may be tracked, generic
source coding can be lever-
aged to identify user paths
and link disparate data
sources. Ideally, marketers
should also consider formal
Media Mix Modeling (an
econometric model which
determines revenue contri-
bution per tactic/program
that accounts for overall
marketing efforts, seasonality and conversion lag times), which
requires substantial campaign setup prior to launch, but can
correlate media exposures/engagement to conversions without
instruments for direct attribution (e.g., source codes and tag-
ging). However, as with any model, it requires marketers to
let ample time for the campaign to make an impact and gather
enough data. Given the need for some level of patience, Media
Mix Modeling is still a particularly attractive solution for mea-
suring DTC campaigns where bridging between consumer
media exposure to actual Rx or product adoption remains a
large gap.
Document key hypotheses/tests in the measure-
ment plan, and allow sufficient time for data to accrue
for statistically significant findings. Data is becoming
increasingly more accessible in real-time, allowing for prompt
in-market optimizations. However, eagerness to optimize has
also led to premature reactions. Adequate sample size is critical
to statistical integrity but is often overlooked when marketers
observe trends only directionally. Rash and frequent optimi-
zations risk dismantling the test plan and might inadvertently
inhibit learnings at the end of the campaign.
Identify connections
Identify key performance indicators (KPIs) that
are aligned with how consumers actually engage with
each channel and across channels. When marketers hold
all tactics against the same objective, the measurement plan
OPTIMIZING ROI
Ogilvy CommonHealth Worldwide’s overall framework for planning, implementing, executing and sustaining
campaign measurement.

Advertise in DTC Perspectives Magazine
Why advertise with us?
• Effi cient Targeting Reach pharmaceutical marketers
for a fraction of the cost than other industry publications
• Engaged Readers Loyal subscribers read us cover-to-
cover, recognizing our content as valuable and relevant to
their business
•Bonus Distribution DTC Perspectives magazine is
also distributed at our DTC National, MDPA & Fall
Conferences
For more information please contact Matt Yavorski at Matt@dtcperspectives.com or 973-239-2051 x224
Value-added packages available for 4 time advertisers.
Opportunity for integrated presence through DTC Perspectives magazine, our website,
e-mails /e-newsletters, and conferences.
REACH THE RIGHT DTC MARKETERS
DTC Perspectives • September 2011 | 19
OPTIMIZING ROI
grows unnecessarily complex and results in channels being
held against unrealistic expectations. The overall objective
of a campaign might be to increase sales, but evaluating all
individual tactics against driving sales would be to overlook
that each channel drives different consumer behaviors toward
conversion. In general, certain tactics are further down the
consumers’ consideration paths and thus produce more direct
attributions to revenue. A common example is the compari-
son between print and SEM. When marketers attempt to hold
print and SEM against the same objective of driving sales,
print typically yields an apparently lower return, prompting
stakeholders to reduce print investment. Instead, the integrated
marketing perspective would suggest that print heightens
awareness and prompts consumer research via SEM.
Focus investment on the select channels that are
truly relevant to the target audience and brand catego-
ry. Some marketers have misinterpreted integrated marketing
as the requirement to create “surround sound” by positioning
the brand in every possible channel – to check all of the pri-
mary media boxes, including TV, print, digital banners, SEM
and social media. However, ROI generally diminishes when
resources are spent unnecessarily or thinly. The measurement
plan also becomes unfocused, as noise from superfluous media
muddles and detracts from evaluating the tactics that were truly
influential to the target audience.
These are exciting times for analytics. Marketers are
continuing to unlock data analytics’ potential in optimizing
investment real-time and in a more targeted way. First step
of successful integration is through the data planning phase
and using data to understand how consumers engage across
most relevant channels. However, as we look to the future,
with data becoming more available and tracking more sophis-
ticated, there are opportunities for marketers to understand
the impact of pulsing versus continued exposure of marketing
efforts.
More research is needed in order to understand how timing
affects the relationship among channels. In addition, further
understanding is needed in integrating the marketing efforts
of different audience types: healthcare professional, patient/
prospect, and pharmacist. Optimal ROI is reached only when
marketers successfully understand and coordinate the relation-
ship of three key factors: audience type, channel mix, and tim-
ing. And it will be the appropriate use and analysis of data that
will enable marketers to achieve this. DTC
Nami Choe is partner, senior director, consulting with Ogilvy
Healthworld. Ogilvy Healthworld is an innovative full service market-
ing agency and a part of Ogilvy CommonHealth Worldwide. Choe
can be reached by telephone at 212-237-4789 or by e-mail at Nami.
Choe@ogilvy.com.

20 | DTC Perspectives • September 2011
I
f change is the Grandmother of Invention (after all, who
do you think begot Necessity?), then the current world
of DTC is like ladies night at the nursing home. There’s a
huge mosh pit of change all around us:
• Almost 75 percent of the biggest DTC spenders will go
generic by the end of 2013. Think about it: Lipitor, Cre-
stor, Plavix, Cymbalta, Viagra, Advair, Boniva, etc. (IMS,
2010)
• There’s been a dramatic shift from mass media to targeted
audience, (e.g., a 23 percent swing from network to cable,
MM&M 2010)
• And, miracle of all miracles, there’s finally a government
agency that admits DTC plays a beneficial role in both
public health and in lowering healthcare costs (The Con-
gressional Budget Committee, May 2011)
Which means DTC is due for some big invention.
In fact, it’d be a shame if we just stood there and kept put-
ting out the same Beauty and the Beast formula of a disease-
stricken patient magically transformed into a walking grin,
interrupted by 32 seconds of fake doctor-patient interaction
while fair balance is read. We have the chance – and respon-
sibility – to respond to the changing landscape with a whole
new vocabulary of action.
What DTC could mean
“Direct to Consumer” says what it is and where it plays.
But effective brands today are built on what they do than what
they are. So imagine if DTC stood for:
D = Do. Do something for consumers beyond dissemi-
nating information. Don’t just stand there at the pulpit and
preach. Add value to your communications by adding utility
to your media. A mobile app (“mHealth”) that empowers a
consumer to do something about their disease, or their care,
can be much more effective in building your brand. Some
other good examples:
1) Is an app that alerts me to when my epinephrine pen
needs replacing worth more than another print ad? It
shows that the brand is actively
engaged in my life, proving its
understanding – not just passively
claiming it.
2) The AllergyManager app (from
Omnaris) gives sufferers an allergy
forecast in their area, along with
information on Omnaris. (But
don’t cheat. Your app has to
be more than just the mobile
version of your website.)
Effective brands are now built on what they do for consumers, rather than what they are. Thus, DTC is
due for some big innovation. By redefining DTC, marketers can truly realize the potential of DTC to
responsibly change consumer healthcare and deliver the coveted: improved outcomes.
by bruCe rooke
It’s Time “DTC”
Stood for
Something Else

DTC Perspectives • September 2011 | 21
3) GoMeals (from Sano-
fi-Aventis) instantly
guides diabetics in
the real world to
what they should eat,
where they can eat,
and helps them watch
what they eat.
4) The Tamiflu cam-
paign* for Roche
where, beyond the
“Happy Feet” danc-
ing penguins, we
gave consumers a
simple mnemonic
to tell the difference
between cold and flu – the F.A.C.T.S. of flu: Fever,
Aches, Chills, Tiredness, and Sudden Symptoms. It gave
caregivers a free diagnostic tool that made them, well,
better caregivers. That’s doing, not just telling.
T = Teach. Equip your consumers to be smarter patients
or more astute caregivers. We love to hide behind the veil of
educating consumers about their health – and then we proceed
to sell in the traditional manner. Let’s truly educate. What if
we walked them through a procedure, step-by-step, fears and
hopes, using a celebrity not as borrowed interest but as the
real consumer (realitylasik.com)? What if we taught men how
to be conversant in controlling uric acid versus medicating
gout pain (Takeda’s Uloric DTC campaign*)? Designer Jacob
Heberlie found the perfect touch in his multiple sclerosis (MS)
animated video series for Dr. Singer’s MS Clinic (mslivingwell.
org) in taking the complex science and therapies and creat-
ing motivating “I get it now” moments for consumers and
caregivers. The year-old GE healthymagination and Howcast
online videos do much of the same (see the case study at how-
cast.com). And the healthymagination/MedHelp app, “I’m
Expecting,” teaches a mom what is going on with her baby
at any given time along the journey. In all of these examples,
smarter consumers equaled more active consumers. And that
teaching leaps over the hurdles and can lead directly to the
brand.
C = Connect. Connect the conversation. Healthcare
decisions are no longer made unilaterally. They include the
consumer (patient), the caregiver(s), the physician, the nurse,
the payer, and the invite list goes on. Plus, under healthcare
reform, team health management will be standard of care
(SOC) at the doctor’s office. So it will take multiple influ-
encers to get to one decision. Which makes connecting that
conversation even more crucial. This doesn’t mean you have
to have the same campaign across all audiences. But it does
mean that somehow in your campaign, you need to inspire
and incentivize a connected conversation. (Yes, beyond the
ol’ “ask your doctor about…”) Besides, you want people talk-
ing about your brand, influencing each other, filling in each
other’s blanks, completing the story – with your brand front
and center.
For example, Eisai realized with Aloxi that the cancer
patient may never speak up about their nausea (for fear of get-
ting reduced, less effective chemo), and the doctor may never
hear the patient complain. So they expanded their campaign
to reach both caregivers and nurses, knowing if they could
connect them, they could create that vital conversation, and
Aloxi would be an important part of the dialogue. The cus-
tomizable e-postcards of Gardasil’s “Tell Someone” campaign*
helped boost awareness from 5 percent to 50 percent. And just
imagine how a Zeo Personal Sleep Coach (www.myzeo.com)
– with all of its tracking data and “ZQ” score – could create
a connected conversation for a branded sleep aid. (Sorry, you
have to imagine it. Hasn’t happened yet.)
So, as you can see, the necessity of change (and the endless
opportunity of digital) has given all of us the chance to make
DTC mean so much more than “Direct to Consumer” (or
“Dull Television Commercials” or even “Diarrhea to Come”).
By redefining DTC to mean Do, Teach, Connect, we can truly
realize the potential of DTC to responsibly change consumer
healthcare and Deliver the Coveted: improved outcomes. DTC
*Denotes campaigns developed by GSW Worldwide.
As chief creative officer, Bruce Rooke provides strategic leadership for
GSW Worldwide’s creative team. His responsibilities include estab-
lishing and implementing standards for creative work and ensuring that
strategic, creative, and branding processes are used consistently across
the agency. Rooke can be reached by e-mail at brooke@gsw-w.com.
REDEFINE DTC

22 | DTC Perspectives • September 2011
Medication
Non-Adherence:
The Health Care Industry’s
Silent Epidemic
In order to increase adherence, marketers need to understand the
consumer behaviors that lead to the original divergence from in-
tended medication use. Based on the FICO Medication Adherence
Score, this article highlights consumer profile examples and explains
the role such generated scores play in the larger pharmaceutical
marketing ecosystem and forecasted scenarios.
by Todd STeffeS
T
he issue of patient adherence to prescription drug regi-
mens hasn’t commanded enough discussion in recent
years, but it has grown into a disturbing trend with sig-
nificant side effects for the health care industry. Not only are
the effects felt by patients, who suffer worse health outcomes
as a result of not taking their medication, but the health care
industry suffers in several ways as well. Chief among these
are increased costs of doing business, providing treatment and
serving patients.
Despite the negative consequences of medication non-
adherence, existing strategies to fight the trend aren’t ade-
quately addressing the problem, and as a result are exposing
patients to greater health risks. The industry as a whole needs
to identify and adopt adherence initiatives that are more pre-
ventative in nature to engage earlier with individuals at risk of
failing to take their medication and keep them on track.
Research shows as many as half of all patients in the U.S.
do not take their medication as prescribed, 31 percent do not
fill prescribed medication, 29 percent stop taking medication
before supply runs out and 24 percent take less than the rec-
ommended dosage1. As you would expect, this has a significant
effect on patient health outcomes; for example, patients with
high blood pressure who do not take medication as prescribed
are more likely to experience complications like coronary
heart disease or stroke. Worst of all, medication non-adher-
ence is estimated to result in around 125,000 premature deaths
in the U.S. each year2.
In addition to detrimental health consequences, non-
adherence adds significant costs to the health care system – the
issue as a whole costs the U.S. health care system $290 billion
each year3, or 13 percent of the total U.S. health care expen-
diture. Furthermore, a 2011 study showed that a non-adherent
patient with high blood pressure spends an average of $3,908
more per year for health care than an adherent patient4. For
congestive heart failure, the additional patient cost is esti-
mated to be $7,823, and for diabetes $3,765. Worse yet, these
social and economic costs are rising, and are likely to continue
unchecked unless current approaches to non-adherence are re-
thought.
Fighting non-adherence today
In recent months, industry leaders have begun to notice
this trend and take action. The National Consumers League
(NCL) and the Surgeon General have announced a three-year
campaign to raise awareness of the importance of medication
adherence. Many prominent health care associations and other
industry leaders are supporting the initiative.
A number of approaches exist today to improve medication
adherence, including (see Figure 1):
• Monitoring: Organizations with access to claims informa-
tion – health care providers and payer organizations – can
monitor patient treatment history and look for gaps.
Unfortunately, this approach only addresses non-adher-
ence after it has occurred, and once treatment has been
stopped it becomes more difficult to re-engage.
• Point-of-care interaction: Health care providers and retail
pharmacies engage in direct communication with patients,
but this is costly and not always accurate. Patients tend to

DTC Perspectives • September 2011 | 23
IMPROVING ADHERENCE
overstate their own prescription usage,
and it’s hard for practitioners to know
which patients are in most need of
counseling. It’s also difficult for these
organizations to decide where their
time and resources are most needed.
• Behavioral surveys: Pharmaceutical
manufacturers have used psychomet-
ric-style surveys to assess current and
future patient adherence behavior.
Though results are useful, responses
often give an incomplete picture of
a patient population because of low
response rates and false or embellished
self-reported information.
• Patient education: Industry organizations
send out mail, e-mails and SMS mes-
sages, and use TV and online channels
to communicate with patients. For
example, pharmaceutical manufactur-
ers like to combine educational mate-
rial with incentives like co-payment
cards to reduce out-of-pocket expenses
for patients. These education strategies can work, but
they are costly because they employ a “one-size-fits-all”
approach and resources are wasted on patients who take
their medication on time and in full.
In sum, there are two primary problems with today’s
approaches to medication non-adherence. First, it’s too late to
impact non-adherence retroactively; it is difficult and costly
to re-engage with a patient and get them back onto their
medication plan after they have already failed to fill a prescrip-
tion. Second, patient engagement strategies need to be more
tailored to specific patient and health condition types, channel-
ing resources to those with the greatest risk of non-adherence.
One-size-fits-all approaches do not effectively accomplish this,
so new solutions are needed to circumvent these challenges
and truly curb medication non-adherence.
Using analytics to focus programs
The use of predictive analytics has emerged as an effective
way to overcome the limitations of current strategies and drive
improved patient medication adherence. These analytic models
can accurately predict who will become non-adherent before
the prescription is written. This could be a real game-changer
in the health care industry – if you can identify which patients
are most at risk of becoming non-adherent, then you can
develop tailored preventative engagement strategies and apply
them to both improve patient health outcomes and save costs.
One approach to do this, like we’ve established with the
new FICO Medication Adherence Score, is to generate a score
early in the course of treatment, when an individual is being
prescribed drugs for the first time. We have learned that it is
important to develop tools that have the greatest flexibility of
application and can be made available to multiple stakeholders.
Leveraging publicly available data sources can provide broad
predictive tools across the entire patient base for enhanced
adherence propensity assessment.
If the score indicates the patient is at higher risk of non-
adherence, a doctor, pharmacy or other organization would
have the opportunity to spend extra time when prescribing the
drugs to emphasize the importance of taking them on time and
in full. After treatment has begun, other intensive engagement
strategies like nurse calls and reminder programs could be used
to reinforce the earlier educational discussions and encourage
adherence. Meanwhile, lower-touch and lower-cost strategies
like e-mails and Web-based educational tools could be used
with lower-risk groups, and co-payment offers could be tai-
lored by risk group as well.
This differentiated approach has the potential to deliver
greater health outcomes and lower costs, compared to tradi-
tional one-size-fits-all approaches. For example, a payer orga-
nization might attempt to improve adherence of new diabetes
patients through a mix of tactics including multiple nurse calls
and counseling sessions – an expensive strategy. Using predic-
tive analytics, the level of nurse interaction could be adjusted
to reflect a patient’s adherence risk ratings; e.g., the com-
pany could reduce levels of nurse outreach to low-risk patients
Figure 1: Solving the Limitations to Current
Non-Adherence Tactics

24 | DTC Perspectives • September 2011
IMPROVING ADHERENCE
(those most likely to adhere) and re-deploy extra resources to
engage higher-risk patients.
Improving outcomes
By using analytics to predict non-adherence, health care
organizations would have the opportunity to experiment with
the most effective combination of engagement tactics for a
particular patient or group – and then standardize what they
learn to be the best practices. Initiatives such as lifestyle advice
and coaching, e-learning programs, financial incentives and
integrating care management with primary care teams are a
few options at their disposal to encourage patients to play a
more active role in their personal treatment. (See Figure 2.)
These kinds of advanced analytic test-and-learn procedures
are already being deployed successfully in the industry. One
FICO client involved in a multi-year disease management
pilot used this approach to engage and retain diabetes and
chronic heart failure patients. Specifically, the company tested
potential messaging to find which would have the most impact
on patients during the first few seconds of a nurse call. The
messaging was pre-tested in focus groups to gauge audience
understanding and responsiveness, and was tested again in a
nationwide attitudinal survey. Then, analytics were used to
search within this survey information and other available data
sources for groups of patients who respond similarly to specific
engagement tactics. The company used these test-and-learn
results to segment patients
into six groups, and to
develop tailored engagement
strategies for each segment.
Results surpassed original
internal patient enrollment
targets by 17 percent, and
exceeded the program spon-
sor’s target by 36 percent.
Advanced test-and-learn
techniques are particularly
relevant now, as health care
organizations consider the
use of new communica-
tion channels such as mobile
and social media. These
approaches provide an effec-
tive way for organizations to
test patient response to both
old and new engagement
tactics, helping them find the
most effective engagement
strategies more quickly and
cost effectively.
Medication non-adher-
ence has become a significant problem for the health care
industry, inflicting harm on patients through poorer health
outcomes and the health care industry through increased
costs. The problem appears to be worsening, in part because
existing preventative engagement and educational approaches
aren’t identifying high-risk patients until it’s too late. New
analytic-based strategies, however, can play an important role
in improving patient engagement initiatives and ultimately
patient adherence. As these strategies take hold and become a
standard industry practice, the health care system and patients
will both benefit from improved medication adherence rates, a
healthier population and reduced expenditure across the health
care spectrum. DTC
References
1 National Council on Patient Information and Education. “Enhancing Prescrip-
tion Medicine Adherence: A National Action Plan” (2007)
2 Norman G. “It takes more than wireless to unbind healthcare.” Presentation at
Healthcare Unbound Conference (2007)
3 Cutler D. & Everett W. “Thinking Outside the Pillbox: A System-wide
Approach to Improving Patient Medication Adherence for Chronic Disease.”
New England Journal of Medicine, 362, 1553-1555 (2010)
4 Medication Adherence Leads To Lower Health Care Use And Costs Despite
Increased Drug Spending, Health Affairs (2011)
Todd Steffes is a vice president at FICO, and the leader of the com-
pany’s health care business unit. For more information on the FICO
Medication Adherence Score, please visit www.fico.com/adherence.
Steffes can be reached by e-mail at toddsteffes@ fico.com.
Figure 2: Personalized Engagement Tactics

Hall of Fame
It’s Time to Celebrate
the Stars of the Industry
Don’t Miss the Chance to Honor these Individuals in Person!
Attend the DTC Hall of Fame Induction Ceremony on October 12, 2011 at the Crowne
Plaza hotel in Fairfi eld, NJ, all a part of the DTC Perspectives fall conference –
Marketing to the Digital Consumer: Pharma Best Practices Present and Future.
Visit our website at www.dtcperspectives.com,
or call us at 973-239-2051 for more information.
Mark Bard
Executive Director and
Co-Founder
Digital Health Coalition
Bill Drummy
Founder and Chief
Executive Offi cer
Heartbeat Ideas
Joan Mikardos
Senior Director Digital
Center of Excellence
Sanofi -Aventis
Nancy Phelan
Executive Director,
Global Communications
Pfi zer

26 | DTC Perspectives • September 2011
I
s there an ideal media strategy to reach and influence a dig-
ital consumer? Is the answer simply intuitive? And does the
answer vary by the disease category? To attempt to discover
the most definitive answer to these questions requires analysis
of DTC categories that share three characteristics: 1) A large
number of branded options, eight or more, 2) Where most
brands use paid media advertising, and 3) Each category using
all four of the most commonly used media strategies, including
TV, print, online display, and brand website.
Study background
The source of data was selected from Phoenix Healthcare’s
Syndicated DTC monthly tracking studies for the first part of
2011. The trackers deploy a method of accurately measuring
advertising exposure to all forms of media advertising each
month, including all branded websites.
The following selective DTC categories were included, to
which most readers of DTC Perspectives magazine could relate
their brand. Data for the months of January through April
2011 was employed in this article, including 13,000 interviews
which involved 31 brands and 146 creatively different ads. In
total, nearly $300 million dollars was spent on the ads tested
for recall of exposure and call to action:
• Lifestyle: Where the patient will choose to ask for and to
use prescription treatment for their purpose, and has the
majority of influence on brand choice; 58 total: 9 TV, 15
Print, 19 Online, 15 Websites;
• Asymptomatic/chronic: Where the need for prescription
treatment is determined through lab work yet the patient
has influence within large choice of brands; 52 total: 11
TV, 17 Print, 16 Online, 8 Websites;
• Symptomatic/chronic: Where patients have differing choices
through various levels of step therapies and where switch-
ing is patient-driven by efficacy to reduce symptoms; 54
total: 4 TV, 20 Print, 22 Online, 8 Websites.
Finding Digital Consumers in a
Sea of Mass Media
How Digital
Consumers
Respond
to Variable
Media Mixes
Winning the battle to drive patient-initiated brand discussion with doctors can quickly focus on the excitable
digital consumers who are so eager in seeking solutions. Using findings from seven syndicated studies, the
authors look at various media strategies to determine successful tactics for reaching the digital consumer in a
sea of mass media.
by J. douglaS Zabor aNd Qi JiaNg

DTC Perspectives • September 2011 | 27
All respondents were classified into digital consumers and
non-digital consumers to focus the analysis on the former
respondent segment. Since each study is a representative
sample of the generalized potential market for each DTC, the
sample of segment of digital consumers is also considered to be
a random sample of that population (see Figure 1).
Simply put, the study design permitted analysts to 1) Deter-
mine precisely which branded advertisements from any media
source a digital consumer was exposed to, and 2) Correlate
variation in advertising exposure to brand-specific behaviors
recommended by the ads. By measuring how actions vary
among patients based on exposure to different media strategies,
it is possible to determine how one medium (or how one spe-
cific creative version of an ad within one medium) provides a
differential contribution to action.
Unlike any other industry where call to action can be as
creative as the core message concepts, the pharmaceutical
industry call to action is regulated by the FDA. Thus, the effi-
cacy of all pharmaceutical ads can be measured comparatively
on proof that exposure to ad resulted in differential behavior
when compared to audience who were not exposed. Those
“Calls to Action” are defined as:
• Talking to your doctor
• Calling an 800 number
• Visiting the brand’s website
Depending on the media configuration used in the month,
each brand was classified into one of four variations of media
utilization:
• Multi-media: Campaigns with branded ads in at least one
mass media (at least TV or national magazine and radio
or newspaper if used), plus online display and the brand’s
website. A total of 10 brands included.
• Mass media: Campaigns with branded ads in at least one
mass media (at least TV or national magazine and radio or
newspaper if used), plus the brand’s website, but no online
display ads. A total of 7 brands included.
• Digital media: Campaigns using only online display ads plus
the brand’s website. A total of 4 brands included.
• Brand site: Brands with no other media besides the brand’s
website. A total of 10 brands included.
For purpose of this analysis, the term campaign means the
aggregation of all creatively unique messages in all media that
month validated by Competitrack along with the branded
website (see Figure 2).
Importance of digital consumers
A digital consumer, for the purpose of this article, is
defined as someone who used the Internet in the last 30 days
to seek information about signs and symptoms, disease infor-
mation, treatments options, prescription medication options
as well as the use of search for brands, for social feedback on
brands from social media, blogs, and including direct brand
site visits. The size of digital consumer market varies in dif-
ferent disease categories. Specifically, the Asymptomatic and
Chronic category has 28 percent of respondents who are
digital consumers, Lifestyle has 45 percent and Symptomatic
has 55 percent.
The patterns intuitively fit the disease impact on the
individual, with those having aggravating symptoms from
a degenerative disease being the most active consumers
of healthcare information on the Internet. Those with an
asymptomatic chronic condition who are placed on long
MEDIA MIXES
Figure 1: Digital Consumer Segment Size of
DTC Category
0%
10%
20%
30%
40%
50%
60%
Asymptomatic &
chronic
Lifestyle Symptomatic, chronic &
degenerative
28%
45%
55%
Figure 2: Media Campaign Types
Multi-media, 10
Mass only, 7
Digital only, 4
Website only, 10

28 | DTC Perspectives • September 2011
term therapy which a physician reviews only periodically, are
the least active. And the lifestyle market is in-between.
A digital consumer is different than a non-digital consumer
in more important ways to pharmaceutical brands than simply
depending more on the Internet for healthcare decision sup-
port. When comparing among branded ad recallers, digital
consumers are significantly more likely to 1) See their physi-
cian in the last three months, 2) Are aware of more brand
choices by name, 3) Discuss more brands as options for treat-
ment with the physician, and, perhaps most importantly, 4)
Are more likely to initiate a discussion about a brand they saw
an ad for than their non-digital counterparts. In combination,
these behavioral attributes make the digital consumer a highly
desirable target for any brand (see Figure 3).
Finding an ideal motivational strategy
It is clear that digital consumers are very targetable consum-
ers who are more responsive to branded advertising than their
non-digital counterparts. But which media strategy should you
choose from to reach this group of consumers?
Across all of the 31 brands, over $300 million was spent: 73
percent on television, 25 percent on print, and 2 percent on
online display. Clear differences can be seen when comparing
non-digital consumers to digital consumers, in terms of stated
exposure to television ads with non-digital consumers stating a
significantly higher recall of TV ads. The opposite, however, is
not true, while non-digital consumers recall fewer online dis-
play ads, the difference is not significant.
Consistently across all three markets, multiple media
achieved the highest level of recall among digital consumers,
followed closely by both mass media and digital. It is no sur-
prise that brand site-only brands achieve the lowest exposure,
but the visibility of these site-only brands justifies their inclu-
sion as a consumer marketing media. Brands relying solely on
their brand website see that these sites stimulate actions second
only to the multi-media campaigns. This finding is true for
both digital and non-digital consumers (see Figure 4).
Surprisingly to some may be that digital media produces
more response per recaller than mass media. Given that digital
media are still most often placed on specific health sites rather
than portals or news media sites’ front pages, this is a media
that needs to be found by the digital consumer in their search
for disease modifying solutions (see Table 1).
Combining the reach by media strategy with the degree to
simulate call to action, the impact on the total market can be
clearly seen. Within this study, multi-media campaigns drove
from two to four times the amount of actions compared to the
other media strategies.
The answer depends on your goals
Seeking volume?
If your brand’s goal is to achieve the largest share-of-voice
in order to impact largest share-of-market action then multi-
MEDIA MIXES
Figure 3: Digital and Non-Digital Consumers
Recalling Branded Ads
0%
10%
20%
30%
40%
50%
60%
70%
Saw doctor last
3 months
Percent of brands
aware of
Discussed campaign
exposed brand with
physician
Initiated discussion
of campaign exposed
brand
64%
60% 59%
54%
50% 53%
26% 28%
Digital Consumer Non-digital consumer
Multi-
Media
Mass
Media
Digital
Media
Brand
Site
Campaign Exposure 72% 43% 38% 16%
Call to Action 51% 30% 36% 49%
Total Market Impact 32% 12% 15% 7%
Cost per response as a ratio
to the cost of digital media
only
24 18 1 N/A
Table 1: Effects of Media Strategies
Figure 4: Percent Recall by Media Type
0%
10%
20%
30%
40%
50%
60%
TV Print Online display Brand website
35%
23%
28%
14%
53%
20% 22%
5%
Digital Consumer Non-digital consumer

DTC Perspectives • September 2011 | 29
media strategy is your solution. A multi-media campaign can
produce the highest recall – the highest conversion-to-action
among those recallers, which adds up to doubling the number
of patients who will discuss our brand with their physician.
This finding is consistent for all three categories even though
ratios of spending in multi-media varied significantly between
the categories.
The volume of patients taking action, however, comes at
a price. Using the cost and the numbers of digital consum-
ers taking action indexed at one, the mixed media campaign
produced 2.4 times more action at 24 times the cost. Response
rates and cost varied within the three markets. For example,
the asymptomatic market mixed media produced 14 times the
number of actions over digital media-only at 14 times the cost,
producing a more justifiable return on investment.
Variations such as that are based on better mix of spend-
ing ratios between the media type, better creative and message
consistency and interest across all media, but the incidence of
patients plays a large role, and the third variable is virulence of
the competitive media environment and the number of adver-
tising competitors.
Brands relying solely on their brand website
see that these sites stimulate actions second
only to the multi-media campaigns.
Seeking impact at lower cost?
If your goal is to reduce or keep media spending down, but
still grow your brand’s reach and influence, then online display
strategy is the best solution to reach the digital consumer. At
24 times less cost than a typical multi-media campaign, online
display ads can reach nearly as many digital consumers as TV.
Within a multi-media campaign, online display ads drive near-
ly a quarter of DTC’s call to action goals. These facts mean
that digital media packs a much bigger punch for the cost than
print or TV.
The silent winner
Campaigns using TV alone, print alone, or even in combi-
nation, produce nearly the same outcomes as an online display
campaign to reach and move digital consumers to take action.
Brands that rely solely on their brand website achieved nearly
equal impact on consumer call to action behavior as mixed
media. Within multi-media campaigns, the brand website con-
tributed nearly a third of the influence to act.
The three disease categories included in this study do have
great variation in size of the digital consumer, media spending
within each media as well as between media strategies. How-
ever, the finding of which media strategy has the largest impact
is consistent across the three disease categories: Lifestyle, Symp-
tomatic/chronic, and Symptomatic/chronic & degenerative.
Recommendations
After the FDA approves the consumer marketing materials,
a brand teams’ hands are tied in terms of improving effective-
ness or efficiency of their campaign to satisfy management.
Among this small set are three actions a brand market can take
to improve campaign effectiveness (impact on market behav-
ior) and efficiency (lowering the cost to trigger that behavior).
Each plan of action should be directly supported by a brand or
DTC tracker to achieve the highest level of decision support.
• Change media spend: Spend more or to spend to reach your
competitive targets and continuously re-allocate spending
between the media to find the optimal mixture to pro-
duce greater response at lower costs.
• Creative asset spend re-allocation: Rapidly determine which
creative assets achieve higher recall along with driving
increased behavior and move your money to those assets
over time to verify the choice was well made.
• Re-balance brand value and promotional value messaging: In
today’s economy and especially to stimulate call to action,
there needs to be a balance in driving home the value of
the brand and providing greater access through lower cost
options, such as saving cards, and building loyalty through
brand site support and on-going support programs.
Above all, make sure you have the breadth and correct
metrics to help you quickly identify a problem or opportunity
that provides quantitative decision support to sustain manage-
ment support. This includes the ability to:
• Measure all brands and all media within a target popula-
tion in order to understand your share of market action
and cost to justify to management;
• Link behaviors with exposure within the dynamic com-
petitive market;
• Measure patient initiated discussion of your brand with
physicians. DTC
J. Douglas Zabor is executive vice president of Phoenix Healthcare’s
syndicated studies. Qi Jiang is vice president of marketing science for
Phoenix Healthcare’s syndicated business. Phoenix Healthcare is a
business unit within Phoenix Marketing International, the nation’s
28th largest marketing research firm. The Healthcare unit tracks over
25 percent of all DTC spending in pharmaceuticals. Zabor can be
reached by e-mail at Doug.Zabor@Phoenixmi.com. Jiang can be con-
tacted via e-mail at Qi.Jiang@Phoenixmi.com.
MEDIA MIXES

Do You Have THE Right Perspective?
Attend DTC Perspectives’ Cutting Edge Conferences
Network With Industry Peers • Learn From Thought Leaders • Celebrate Excellence in DTC
Advertising • Focus on The Latest Challenges • Glean Insights From New Research
Stay on the Cutting Edge
Marketing to the Digital Consumer Conference:
Pharma Best Practices Present and Future
October 12-13, 2011, Crowne Plaza,
Fairfi eld, NJ
Focused on digital and social media
featuring the latest trends, what’s
possible and where there’s potential for
brand improvement.
The DTC National Conference – The
Forum for DTC Thought Leaders
April 10-12, 2012, JW Marriot, Washington DC
Regarded in the industry as the “must attend conference
of the year,” this three-day event brings together
best-in-class industry experts, thought leaders
and marketing gurus to address industry
members.
Don’t Miss these Upcoming DTC Perspectives’ Conferences…
Sign Up Online Now to Receive Email Updates and Exclusive Pass Discounts • www.dtcperspectives.com
Get The Right Perspective...
Sign Up Online Now to Receive Agenda
Updates and Exclusive Pass
Discounts Directly to Your Inbox
www.dtcperspectives.com
REGISTRATION
OPEN NOW
www.dtcperspectives.com • 973-239-2051

Do You Have THE Right Perspective?
PERSPECTIVES
www.dtcperspectives.com
973-239-2051
Gain Industry Insights to Apply to Your Brand
with DTC Perspectives’ Up To the Minute Content
Glean Insights From Latest Research • Application of Newest Spending Data
Stay on the Cutting Edge • Read Analysis from Industry Thought Leaders
Benefi t from Expert POVs and Advice
DTC Perspectives Magazine – The Quarterly
Resource For DTC Thought Leaders
Free Publication for DTC Marketers. Read by industry
leaders for over a decade, DTC Perspectives is the
industry’s only magazine devoted exclusively to DTC
marketing.
DTC in Perspective –
by CEO Bob Ehrlich
A Must-Read Weekly eColumn
Delivered Every Friday Morning to Your Inbox. A weekly blog column from
our chief executive offi cer Bob Ehrlich refl ects his observations on key
trends affecting our industry.
From DTC Perspectives Print, Email and Online Content…
Sign Up Online Now to Receive a Free Subscribtion and Bob’s Weekly EColumn • www.dtcperspectives.com
DTC Perspectives • March 2011 | 35
Turning Insights into Innovation
Regional marketing identifies specific opportunities for sales growth and market share that national marketing
plans may not fully recognize. Understanding market variations and the key drivers behind these variations,
brand marketers can enhance a marketing plan with regional strategy, plan development and deployment,
leading to an increase in a brand’s sales performance.
by Scott Weintraub
R
egional marketing is a concept whose time has come.
As companies in the pharmaceutical, biotech and medi-
cal device (global change) markets begin to embrace
the idea, the question becomes: “How do we make regional
marketing a reality?”
First, let’s take a closer look at regional marketing. Regional
marketing is a targeted allocation of resources to markets / dis-
tricts for the greatest return on investment (ROI). It is a strat-
egy that relies on understanding regional variability and how
to harness it in order to maximize results. Marketers should
deploy regional marketing when variations exist among payer,
provider, prescriber, population, product, or place.
Regional marketing consists of grouping similar markets
based on common drivers and developing marketing strategies
utilizing key market drivers. With regional marketing, it is local
differences that help determine how to efficiently direct avail-
able resources. It is important to have a rapid deployment team
ready to take advantage of local market changes as they hap-
pen. The overall objective is to drive product performance and
improve ROI through efficient resource deployment and allo-
cation. Other benefits of regional marketing include reduced
program waste and improved productivity for the marketing
and sales teams.
Establishing your plan of action
Regional marketing consists of three disciplines: regional
strategy, regional plan development and regional deployment.
Regional Strategy – In this initial step, assess the many
factors influencing brand performance in each market and
evaluate the company’s capabilities for handling regional
marketing. Next, develop a vision for how regional mar-
keting innovation can help your brand. Then work to gain
The Regional
Marketing Roadmap
REVIEW
Overall DTC Spending Declines 9.2% in Q1-3 2010
Pfizer Producing Seven of Top 20 Promoting Brands
Brand Manufacturer Q1-3 2009 Q1-3 2010 $ Change % Change
Lipitor Pfizer $155,572,800 $204,795,300 $49,222,500 31.64%
Advair Diskus GlaxoSmithKline $128,696,300 $169,488,400 $40,792,100 31.70%
Cialis Lilly USA $122,028,600 $158,180,200 $36,151,600 29.63%
Cymbalta Lilly USA $141,415,900 $146,388,000 $4,972,100 3.52%
Abilify Otsuka America / Bristol-Myers $150,136,800 $122,396,800 -$27,740,000 -18.48%
Pristiq Pfizer $70,691,300 $112,960,000 $42,268,700 59.79%
Plavix Bristol-Myers / Sanofi-Aventis $113,096,800 $103,544,600 -$9,552,200 -8.45%
Symbicort AstraZeneca $91,483,100 $102,071,200 $10,588,100 11.57%
Chantix Pfizer $38,671,500 $99,514,300 $60,842,800 157.33%
Lyrica Pfizer $114,818,900 $93,164,900 -$21,654,000 -18.86%
Toviaz Pfizer $23,262,500 $84,171,300 $60,908,800 261.83%
Lovaza GlaxoSmithKline $5,162,400 $79,893,800 $74,731,400 1,447.61%
Crestor AstraZeneca $96,436,200 $79,032,100 -$17,404,100 -18.05%
Singulair Merck & Co. $70,680,700 $67,844,800 -$2,835,900 -4.01%
Viagra Pfizer $88,636,200 $65,682,100 -$22,954,100 -25.90%
Simponi Centocor Ortho Biotech $124,400 $61,884,000 $61,759,600
49,645.98%
Trilipix Abbott Laboratories $39,750,400 $56,349,100 $16,598,700 41.76%
Boniva Roche / Genentech $61,381,200 $55,535,300 -$5,845,900 -9.52%
Vyvanse Shire $73,207,700 $52,821,800 -$20,385,900 -27.85%
Spiriva Boehringer Ingelheim / Pfizer $56,565,600 $51,757,100 -$4,808,500 -8.50%
Total Spending for Top 20 Brands $1,641,819,600 $1,967,475,100 $325,655,500 19.84%
Total Pharma Spending $3,381,974,400 $3,070,994,000 -$310,980,400 -9.20%
Media Type Q1-3 2009 Q1-3 2010 $ Change % Change
56%
Television $2,105,347,200 $1,730,615,800 -$374,731,400 -17.80%
32%
Magazine $932,512,200 $972,458,400 $39,946,200 4.28%
6%
Newspaper $103,542,700 $186,098,000 $82,555,300 79.73%
5%
Internet $218,069,900 $154,266,200 -$63,803,700 -29.26%
1%
Radio $19,552,300 $25,226,300 $5,674,000 29.02%
0%
Outdoor $2,950,100 $2,329,200 -$620,900 -21.05%
Total Pharma
Spending
$3,381,974,400 $3,070,994,000 -$310,980,400 -9.20%
Source: Kantar Media for DTC Perspectives, Copyright 2011.
Established in more than 50 countries, Kantar Media helps clients master the world’s multimedia momentum through analysis of print, radio, TV, Internet, cinema, mobile, social media,
and outdoor worldwide. Kantar Media offers a full range of media insights and audience measurement services through its global business sectors – Intelligence, Audiences, TGI and Cus-
tom. Kantar Media companies also include Compete, Cymfony and SRDS. Drawing upon the deepest expertise in the industry, Kantar Media tracks more than 3 million brands and
delivers insight to more than 22,000 customers worldwide. www.KantarMediaNA.com. For more information, send an e-mail to David Wood at David.Wood@kantarmedia.com.
0%
1%
6% 5%
32% 56%
Newspaper Seeing Significant Uptick in DTC Spend in Q1-3 2010
While TV and Internet Lose Slight Market Share
12 | DTC Perspectives • March 2011
The Source For DTC Leaders
PERSPECTIVES
Vol. 10, No. 1 March 2011
PRST STD
U.S. Postage
PAID
Permit #108
Lebanon Junction
KY 40150
DTC PERSPECTIVES, INC.
110 Fairview Avenue, Suite 4
Verona, NJ 07044
CHANGE SERVICE
REQUESTED
Savings Offers: Reach
The Right Audience
Which Comes First,
The Website or Ad?
Using Posting Analysis
to Gain Competitive
Intelligence
Driving Product Demand
With New Strategies
In This Issue
Galvanizing Marketing
Communications
Six Key Skills of a Future Brand Champion
Get The Right Perspective...
Sign Up Online Now to Receive Your Free Subscription
www.dtcperspectives.com

32 | DTC Perspectives • September 2011
Don’t Overlook the
Long-Tail Internet as a
Viable Content Source
Pharma marketers face a number of unique challenges
in digital advertising: achieving scale, reach, brand
safety, cost-effectiveness and FDA compliance, to
name a few. Marketers can reach their appropriate
audiences, all while maintaining compliance with
FDA regulations, by utilizing “smart targets,” which
map online and offline data to content consumption
patterns.
by TaNayia WaShiNgToN
D
igital marketers face many challenges in identifying
and reaching their target audiences, including such
issues as what channels to use, how much to invest
in each and brand versus direct spend. Pharma digital market-
ers face additional challenges – stricter privacy restrictions on
customer targeting and the use of online data, heightened con-
cerns over brand safety, expensive premium health content and
low customer interactivity.
Despite these challenges, pharma investment in digital
media is robust – $1 billion in 2010, according to eMarketer.
Yet at this investment level, the stakes are high to deliver
strong results in a cost-effective manner, all while maintaining
federal compliance and ensuring brand-safe ad environments.
While the use of cookie targeting is fairly common in other
industries, it is avoided by pharmas due to concerns over con-
sumer data privacy – think HIPAA regulations – even though
it is not outright forbidden by the FDA. But a replacement for
this type of effective targeting is not easy to find.
Another challenge: the lack of interaction with online ads.
According to a MediaMind study1, standard and rich media
click-through rates (CTR) are half as high for pharmaceutical
ads as they are for those in other industries. Pharma marketers
seem to still be interested in click-through because it can serve
as an indication of interest and is widely used for display cam-
paign measurement and optimization, especially in the absence
of online purchase metrics.
Given these challenges, there are four key questions pharma
marketers need to ask in order to ensure their digital strategy is
on track:
• How can I identify my target audience? Because
cookies generally aren’t an option, you need to find other
ways to gain a deeper understanding of who your audi-
ence is.
• How can I reach them at scale? Any audience insights
gained must be leveraged to broaden the scope of cam-
paigns in order to make the best use of digital investments.
• Can I reach my target safely? Unless you can guar-
antee brand-safe environments, nothing else matters in
pharma marketing.
• Am I reaching my target effectively? What is the
optimal mix of targeting tactics that will achieve campaign
goals (reach, brand lift, clicks, page environment) while
maintaining regulatory compliance?
The digital advertising industry as a whole is under the glare
of the data privacy cops. To ward off threats of federal inter-
vention, the industry is developing voluntary, self-governing
privacy standards. In this environment, pharma marketers not
only have to satisfy overall industry standards, but also need to
Memo to Digital Pharma Marketers:

DTC Perspectives • September 2011 | 33
adhere to stringent federal requirements on everything from
privacy to creative copy.
Limited and costly inventory
As most pharma marketers naturally want to have their ads
appear next to health-related content specific to their prod-
uct, the laws of supply and demand have pushed the price
of impressions up. According to comScore, health display ad
impressions grew by 56 percent between December 2009 and
December 2010, while unique visitor growth was just 29 per-
cent, and page views only grew 11 percent. Thus, the number
of ads per page increased by 41 percent, creating clutter and
ultimately brand dilution and diminished ad performance.
As mentioned above, the limited supply of premium online
health content has pushed costs higher. While pharmas may
have a greater tolerance for higher costs, they’re still looking
for efficiencies. According to the December 2010 comScore
Ad Metrix Display Spend Report2, health sites charged an
average CPM (cost per thousand impressions) of $8.94 –
nearly four times the overall average CPM of $2.36. Auto and
finance were the only vertical categories with higher CPMs.
Brand safety
Having an online ad appear next to inappropriate content
– profanity, pornography, etc. – is a bad result for any mar-
keter, reflecting poorly on the brand and adversely affecting
campaign results. For pharma marketers, the result could be
more serious if the placement targets a restricted audience and
could be construed as promoting an off-label usage, drawing
unwanted FDA attention.
The critical nature of this issue is borne out in research
from The Winterberry Group3, which found that pharma mar-
keters consider brand safety of greater importance than those
in other vertical markets. For instance, consider the growth
of online user-generated content, especially blogs.
While a major CPG brand might welcome the
association with such content, especially in a target
demographic, pharma marketers would steer clear of
it as the quality of the relatively un-vetted content
could be suspect and adversely affect brand health.
The Interactive Advertising Bureau (IAB) cre-
ated a set of content quality standards in June 2010,
outlining categories of non-standard and prohibited
content. More recently, the IAB created voluntary
Quality Assurance Guidelines, with IAB certifi-
cation ensuring advertisers full transparency and
safety. While these are valuable tools for advertisers,
pharma marketers need to go above and beyond
such measures, using their own stricter brand safety
definitions.
To overcome these challenges, you need to
develop a holistic approach that addresses all of
them. Otherwise, you risk devaluing your brand, limiting
digital spend through lack of effectiveness or inciting the ire
of regulators. The best solution is a multi-pronged approach
that provides targeting, scalability, compliance and brand safety
while not sacrificing effectiveness.
An overlooked resource
Because using cookies for gathering consumer data and tar-
geting audiences is not really an option for pharma marketers,
you have to find creative ways to get around this restriction
and gain the necessary audience insights. One very effective,
cost-efficient way for to reach your target audience at scale is
by using the so-called long-tail Internet. It is composed of mil-
lions of websites that are not as heavily trafficked as popular
destinations – for example, Everyday Health or WebMD in
the health category.
While not a replacement for premium health content, a
strategic use of long-tail content can provide much greater
reach and be an efficient use of digital media budget. Accord-
ing to comScore4, using long-tail inventory had the potential
to increase reach by well over 200 percent among consum-
ers either searching for information on a particular ailment or
buying a prescription for it. When adding in non-health con-
tent from the long tail, reach potential increased by more than
600 percent5.
Again, health content is the obvious starting point for any
pharma marketer, but it shouldn’t stop there. A mix of short-
tail and long-tail content, both health and non-health-related,
can be an effective combination. Additionally, insights on
what content target audiences are consuming can be used to
improve the precision of targeting without running afoul of
privacy restrictions.
LONG-TAIL MARKETING
Figure 1: Reach with a Targeted Content Mix

34 | DTC Perspectives • September 2011
LONG-TAIL MARKETING
In order to understand and target what content audiences
are consuming, you must know who this audience is beyond
the condition they suffer from. However, this is not often
the case. CONTEXTWEB found in its research than only 29
percent of pharma marketers were providing additional target
information like demographic data to their media partners, and
just 8 percent were providing interest data.
This lack of insight led CONTEXTWEB to conduct an in-
depth study to determine the profile of consumers interested in
pharma advertising. The study combined leading third-party
audience data with proprietary system data to analyze action
patterns, in this case clicks on pharma ads.
The resulting “Smart Target” profile revealed that the ideal
“pharma desirable” is an early retirement boomer, age 56 and
up, living in a city and having older children who are grown
or entering college. They’re college educated with mid- to
high-level incomes but are not big spenders. While obviously
interested in health content given their age, they also consume
content on a wide range of subjects. Importantly for advertis-
ers, they are more likely to respond to a richer display media
experience.
Once you know the
profile of your audience,
you need to leverage
those insights in order
to tap into non-health,
long-tail content and
reach them at scale. As
part of the media budget
planning process, you
need to know which
content channels to invest
in first in order to use a
targeted approach. In its
research, CONTEXT-
WEB reviewed data on content consumption patterns
for the pharma Smart Target. By analyzing billions of
impressions, it created a statistically significant, refined
custom content channel for this audience, called a
“Hotspot.”
Reaching the target safely
To ensure your ads don’t appear next to inappro-
priate content, this needs to be checked both before
and after ad serving. When using ad networks and
exchanges, publisher screening must be rigorous and
continuous because online content changes con-
stantly. It must also be done in real time and down to
the individual page level in order to block potentially
harmful Web pages that may come from an otherwise
safe domain. Ideally this process should be customiz-
able for every advertiser.
Just what constitutes brand-appropriate content is highly
subjective and differs widely by industry and even by com-
pany. This is why pharma marketers use their own manual
methods of checking content safety. But this makes it hard to
scale beyond short-tail health sites, leaving broader inventory
sources such as networks or exchanges out of the equation.
However, brand safety and scale don’t have to be mutu-
ally exclusive if you use automated machine learning that can
mimic your brand’s sensibilities in order to scale safely.
The impact
While understanding your audience and finding new ways
to reach them safely is important, it means nothing if your
tactics aren’t helping you hit your campaign goals. Based on its
research, CONTEXTWEB found that the most effective strat-
egy for pharma marketers is using a mix of targeting tactics,
with each contributing to an increase in digital media perfor-
mance if used properly.
Reach
Blending health and non-health content doesn’t have to
be done at the expense of hyper-targeting. Pharma campaigns
Figure 2: Brand Awareness Lift by Content Category for a
Prescription Gout Brand Campaign (vs. control)
Figure 3: Lift Generated by Targeting Tactic

DTC Perspectives • September 2011 | 35
LONG-TAIL MARKETING
you should take into
consideration as part
of any pharma adver-
tising buy, helping
determine domain
and content priorities.
Trust Metrics,
which took part in
the CONTEXTWEB
research, scored 2,000
Web domains that
ran pharma ads on
the CONTEXWEB
platform in Q4 of
2010. The score was
computed based on
the statistical pat-
terns of more than
12,000 data points on
each site, with results
reported on a 0-100
scale. Sites scoring
above 61 were gener-
ally considered to provide a premium value to advertisers.
By combining CTR, CPC and quality score ratings, CON-
TEXTWEB came up with an overall average index value for
sites within a content category, as seen in Figure 4. While
some categories were found to be stronger in performance
than in quality or vice versa, the average index ranking sug-
gests that non-health content such as education, news and
travel would make excellent all-around choices for pharma
marketers.
Strict regulations and ongoing online privacy concerns over
digital marketing make finding effective ways to reach target
audiences at scale a particularly thorny problem for pharma
marketers. For this reason, you need to seek out alternative,
compliant targeting strategies. This involves getting creative by
implementing tactics that go beyond the traditional heavy reli-
ance on health-related content. With the right approach and
mix of tactics, brand safety, targeting at scale and consumer
privacy can all peacefully coexist within the context of a holis-
tic digital marketing strategy. DTC
References
1 MediaMind, “Benchmarks H1 2011,” April 3, 2011, via eMarketer
2 comScore Ad Metrix Trend Report, February 2011
3 eMarketer, Winterberry Group Research, “Advertising Professionals in North
America Who Believe that Brand Safety is a Meaningful Issue,” April 2010
4 comScore Plan Metrix, December 2010
5 ibid
Tanayia Washington is insights and analytics manager for the digi-
tal media services firm CONTEXTWEB. CONTEXTWEB is a
real-time contextual advertising solutions provider for online advertising
and publishing. Washington can be reached by e-mail at twashing-
ton@contextweb.com.
employing mixed content are able to reach the intended con-
sumer. Figure 1 illustrates how sufferers of specific conditions
were reached by targeting a mix of content.
Brand lift
For pharma marketers, brand awareness is a key metric
because it’s the first step in getting their product on a condi-
tion sufferer’s radar screen. In its research, CONTEXTWEB
found that while health-related content was the most effective
brand awareness driver, non-health content could also have an
impact. Figure 2 shows the results of exposure to prescription
gout ads on three different contextual environments, with
health-related content having the greatest effect.
Clicks
CONTEXTWEB also found that using Hotspot targeting in
pharma with non-health content can have higher CTRs (70
percent above the average) than targeting health content alone
and is 24 percent more cost effective in terms of cost per click
(CPC). Health content was more effective in terms of driving
higher CTRs than run-of-network (RON), but not as effi-
cient due to higher costs. RON placements were not as effec-
tive as content targeting in terms of CTR but were highly
efficient – often a strong consideration for pharma advertisers
(see Figure 3). Overall, CONTEXTWEB found using a mix
of the long tail produced a 15 percent higher CTR on pharma
campaigns.
Quality
Content quality and site environment are also impor-
tant considerations affecting brand perception. Page design,
editorial quality and visitor usage are environmental factors
Figure 4: Click and Qualitative Performance by Category

36 | DTC Perspectives • September 2011
In an ideal world, there would be no limits when creating a relationship marketing campaign. However, in
reality, every marketer has to deal with some type of constraint, whether it be budgetary, time or regulatory.
Drawing from an actual case study, this article discusses key steps for developing RM strategies.
by louiS WiNokur
I
t was a sunny day in June when we met with our new-
est pharma client. They had a great new product that had
come out of clinical trials with stunning results. Everybody
was excited about the new drug which had been approved by
the FDA in record time.
When it became time to discuss the budget, we learned
that the sky was the limit. We were asked to create 5-10
concepts and not to worry about timelines as it was impor-
tant to have the right “feel” for the campaign. To our sur-
prise, the normal copy restrictions did not apply for this
product. Because the audience was thought to be affluent and
well educated, we could write communications in “iambic
pentameter,” assuming the target audience had the equivalent
of a Ph.D. in English.
Gaining access to qualitative information
provides insight into what factors influence
patient behavior.
Generous marketing and media budgets were approved in
what seemed like the wink of an eye. A battery of longitudi-
nal market research tests was also approved including: Focus
Groups, Concept Tests, Intercept and Re-contact studies.
Our client strategy meetings were held in the famous Burj
Al Arab “sail hotel” in Dubai. Relaxing in my luxurious 1,000
square foot suite looking out on the Gulf of Oman, it was hard
to imagine how life could get any better …
Then I woke up.
Back in the here and now, we know the new real-
ity is that times are tough and budgets are tight. Regula-
tory restrictions are an everyday reality. Timelines should be
reasonable and deadlines must be met. Despite these truths,
there is still room for resourceful and creative companies to
shine. Speaking from a research point of view, there are a
few simple tactics that can be employed to ensure that pro-
grams run at maximum efficiency.
To say that programs run in a loop is nothing new. In the
world of RM, the flow to ensure strong results goes along
the following lines, as seen in Figure 1. The chart represents a
holistic view of how we should think about programs – from
their initial creation through optimizations that occur over
time.
Know your audience
The first step, “know your audience” is not always given
the attention it deserves in the initial stages of program devel-
opment. The internal analytics team should be brought in at
this early stage to help assess the value of the target audience.
What a Wonderful World
it Would Be

DTC Perspectives • September 2011 | 37
RELATIONSHIP MARKETING
There are many great resources available to the pharma
community about disease states and the affected population.
The first place to start is with the Prescribing Information doc-
ument. This is where information on dosing, effectiveness, and
common side effects of treatment can be found. It also often
points the way towards segmentation strategy. Other resources
such as the CDC, WebMD, or other health related sites can
provide important background information. For Oncology,
the Cancer Facts and Figures report published by the Ameri-
can Cancer Society is an invaluable resource for learning about
patient populations (see Figure 2).
Speaking to client contacts who work on the brand or
counterparts in the research department is also very important
and will help the analytics team avoid the pitfall of proposing a
redundant study when research data may already be available.
Information from the research department on drug costs
and lifetime value will provide valuable inputs for the ROI
model. Gaining access to qualitative information provides
insight into what factors influence patient behavior. This data
will be useful to the creative team as they formulate the pro-
gram design.
Our recent experience with a new client showed the
advantage of this approach. Existing client data provided
us with information on the patient population (>300,000
strong), demographics (90 percent-plus female), and ethnicity
(63 percent Caucasian). We also learned about segmentation
strategies and initial reaction of HCP’s, including their likeli-
ness to prescribe.
Communicating with the internal research department
allowed us to leverage internal funds to conduct a quick focus
group study, which avoided redundancy and saved them
$50,000. Results from that research helped us understand
ways to motivate patients to increase adherence which in turn
helped crystallize the contact strategy.
Create a measurement plan
The best brand managers in the world will have trouble
getting their budgets renewed if they are unable to find a way
to show why their program was successful. Without advanced
planning, they will be forced to frantically ask for data on vari-
ous program metrics, but will fall short when they realize that
there are gaping holes in the information because measurement
was not thought about in advance.
The key questions to ask is: “What does success look like?”
For the new client program noted in the previous section,
we put together a presentation which outlined what they
should expect from the RM program over the first 12 months
after launch. Based on the media plan, we knew that close to
10,000 people would join the program, of which 80 percent
would be diagnosed with the condition. Using historical data
from past programs and evaluating the program design, we
expected the open rate to be in excess of 15 percent and click
rates to be 4 percent or greater. Other targets were set based
on similar criteria, such as an expected reach of 30 percent and
the percent of enrollees who would report that their knowl-
edge if the disease state and treatment options had increased.
Once targets are established, a measurement plan can be put
into place to capture the important metrics. The plan should
Figure 2: Cancer Patient Populations
Figure 1: Holistic View of Relationship
Marketing

38 | DTC Perspectives • September 2011
RELATIONSHIP MARKETING
extend over the length of the program and involve both inter-
nal and external resources.
Great! Now that initial research data has been acquired and
a measurement plan is in place, we’re home free, right? Not
exactly.
Maximize enrollment
Various factors must be considered when thinking about
how to maximize enrollment. The program design and devel-
opment process can be thought of as similar to the construc-
tion of a high-performance sports car. The account, creative,
and design teams at an agency take great care designing a
seamless user experience with useful content, which provides
the target audience with everything they need to know about
a disease state and its treatment options.
The media plan and enrollment form can be thought of as
the fuel that drives the program. A 2011 Ferrari Enzo’s 660
horsepower can’t beat a rusted-out 1970 Chevy Vega if there
isn’t any gas in the tank. Without fail, whenever we have
come across dramatic drops in enrollment form traffic from
month to month, the culprit has been either a drop in media
spend or a co-reg vendor that has “gone dark” due to the
recent completion of an enrollment goal.
Information from the research department
on drug costs and lifetime value will provide
valuable inputs for the ROI model.
Keeping this in mind, the enrollment form must have an
enticing value proposition and should include the minimum
amount of questions needed to segment consumers. Leave out
questions that are “nice to know” and only include what you
“need to know.” The surest way to cause people to abandon
your form in droves is to offer a weak value proposition and
adopt a long-winded, complex, multiple-page design. Enroll-
ment testing should be incorporated into the plan to under-
stand how people are interacting with the form.
We recently invested in a Web tool that closely tracks
interaction with RM enrollment forms. Initial analytics have
provided surprising results. One client’s two step form had an
abandon rate in excess of 90 percent for Step 1 of a two-step
form. Another had issues with getting consistent engagement
with fields that were “below the fold.” Heat map information
shows how strongly people interact with headlines and other
important copy. For a small up-front investment, these new
data points pointed the way towards improving enrollment
rates across multiple programs.
Recommending the proper media plan is outside of the
scope of this article, but experience shows that for the most
part, it is better to plan for a steady stream of enrollments than
to adopt a plan that is front or back-loaded. In the example
seen in Figure 3, a successful patient-education microsite and
enrollment vehicle fell flat on its face as site visits declined by
97 percent when the client decided to cut media due to bud-
getary constraints.
Once people join an RM program, they are exposed to a
variety of content. The focus of most programs involves edu-
cation about a disease state. Education can include information
about symptom tracking, topics to discuss with your doctor,
common side effects, and exercise and diet tips to help people
feel their best.
Optimize content
Marketers must be aware of how people interact with the
information that is presented to them. At the very least, e-mail
open and click rates
should be monitored
and compared to
either an industry or
internal benchmark.
After a sufficient
amount of data has
been collected, we
often undertake the
extra step of conduct-
ing an in-depth anal-
ysis of click patterns
within communica-
tions. This provides
direct evidence of
which content is of
most interest and if
placement in a callout
box or other primary
location has an effect
on engagement.
In the Figure 4,
we analyzed e-mail
Figure 3: Website - Monthly Unique Visitors
Figure 4: Average Share
of Clicks by Callout Box

DTC Perspectives • September 2011 | 39
click patterns across three patient segments for a program
geared towards sufferers of a chronic condition. We found
that the “On Drug” segment responded strongly to content,
regardless of placement. The body text received 55 percent
of all clicks, even though the links in this section were not in
callout boxes. In addition, we found that “Outside Links”
to other websites attracted 20 percent of clicks despite the
fact that this callout box was at the bottom of the page.
This was contrary to the popular theory that the majority of
clicks always occur above the fold.
This data pointed to a need for a streamlined design for
future phases of the project. For example, we recommended
that the “Tell-a-Friend” (TAF) feature would work better
if it were taken out of the sidebar and featured in a specific
portion of the body text.
Planning is an important part of the optimization pro-
cess. New competitors will invariably enter the market.
Information on best practices for treatment of disease states
changes over time. Meanwhile, technology continues to
evolve, providing new ways for people to access and absorb
information. Metrics that were once robust may begin
to decline due to any or all of the above factors. Regular
evaluation of engagement metrics will provide direction as
to when a change is warranted.
For these reasons, a back end re-contact study is a must-
have to ensure that conversion and adherence goals are pro-
gressing as expected. Dollars spent on evaluating program
measurement are a wise investment. The resulting data will
point to areas for course-corrections that will improve pro-
gram efficiency and boost ROI. Past studies have provided
us with valuable input which pointed the way to improv-
ing value propositions or updating content so that it had a
greater impact on enrollees.
The important message to take away is the only way to
run a “lean and mean” RM program is to know your audi-
ence, create a plan to measure results, find a way to reach
them, and remember to optimize the content along the
way. These days, it is especially important to map out a plan
and to be prepared to make adjustments along the way to
ensure success. DTC
Louis Winokur is currently the director of analytics at DKI. With
over 15 years of marketing experience across analytics, client consult-
ing and product development, Winokur has worked extensively on
consumer segmentation and analysis of purchase patterns across various
products and categories. He can be contacted via e-mail at lwinokur@
dkidirect.com.
RELATIONSHIP MARKETING
Custom Reprints
Take advantage of your profile
in DTC Perspectives Magazine
by ordering custom reprints
of your article or mention.
For more information,
please call Jennifer Haug at
973-457-5718 or email
at Jennifer@dtcperspectives.com
“GET ME
COPIES
OF THAT
ARTICLE”

April 10-12
2012
DTCNATIONAL
CONFERENCE
Visit www.DTCPerspectives.com to
fi nd agenda details, sign up for email
updates and register for the Conference.
Brought to you by pharma,
for pharma, the DTC National
Conference is designed to address
the key issues facing DTC Marketers,
providing delegates with an
opportunity to learn from industry
thought leaders and discuss the latest
innovations in DTC marketing. The
500-plus industry professionals in
attendance will benefi t from case
studies, new market research, media
& marketing gurus and networking
opportunities over three days.
SAVE THIS DATE
REGISTER NOW
WASHINGTON DC
JW Marriott Hotel
For more information call 973-239-2051
#DTCN2012
DTC Perspectives
Events Group
For
All DTC
Thought
Leaders
THE FORUM FOR
DTC THOUGHT LEADERS
NATIONAL

DTC Perspectives • September 2011 | 41
Reinventing Healthcare Marketing in a Connected World
With emerging connections via technological advances, there is a confluence of health data and information
widely available to consumers. Marketers who begin to engage in the anywhere health space will be
positioned well ahead of the curve, reaching customers in new and engaging ways.
by Jim Walker
I
n a remote village outside of Nairobi, a healthcare worker
walking to a makeshift clinic makes sure to bring her mobile
phone along with a stethoscope so that patient vital signs
can be immediately texted back to the hospital. Along the trails
outside of Seattle, a runner training for a marathon glances at
his watch and knows his exact location, heart rate, and body
temperature. In Houston, a teenager uses her inhaler for an
asthma attack, and her location is sent automatically to an online
database. A physician in Philadelphia clicks on his iPad and has
immediate access to CT scans from the ER. An elderly woman
in Osaka flushes her toilet, and is alerted that her blood sugar is
too high. An elderly man collapses at a church service in Atlanta
and is revived by a portable defibrillator. A mother from New
York posts a brief message about her son’s illness on Facebook,
and a few minutes later a friend alerts her that it’s a serious con-
dition. An overweight man steps on the scale in London and his
weight and BMI are automatically sent to his iPhone where he
can track his progress over time. He touches his phone and the
data is made available to his physician. A mother in Chicago
goes to the drugstore and uses her smartphone in the aisle to
find coupons for children’s pain medicine.
Each day around the world, scenes like these are occurring
with increasing frequency as the combined impact of portable
devices, wireless Internet access, and social networks revolu-
tionize the ways by which patients are diagnosed, monitored,
and treated. The common threads that link these stories – any-
where diagnosis, anywhere data, and anywhere delivery – are
powerful and far-reaching, and together form the foundation
for anywhere health.
Clearly this phenomenon is going to have a dramatic
impact on both patients and HCPs, but what impact will this
anywhere health revolution have on healthcare communica-
tions and marketing? Many marketing teams have already
begun to address various channels such as mobile marketing,
iPad development, and Facebook social marketing. However,
the larger opportunity and challenge lies in creating integrated
marketing programs that take into account the entire any-
where health landscape.
While all of these dynamic medical technologies will con-
tinue to evolve, some core principles are emerging that pro-
vide practical and ongoing guidance when formulating brand
strategies and tactics in an anywhere health world.
Anywhere Health

42 | DTC Perspectives • September 2011
Start with the patient
Up until very recently, tracking personal data and vital
signs was the sole province of hospital units or elite athletic
programs. However, that model is in the process of being
completely overturned as low-cost devices and powerful data-
tracking sites flood into the market, allowing for personal
tracking at levels previously undreamed of. Today, devices and
their accompanying websites can help individuals track fitness,
health, sleep, mood, productivity, energy, location, money,
social media patterns, learning and more! When the personal
data and insights from these devices are then shared and dis-
cussed on social sites like Facebook or PatientsLikeMe, the
resulting feedback loops can be powerful, if not transformative.
Quite simply, the data-rich anywhere health environment is
sparking an unprecedented rise in patient sophistication regard-
ing his or her own particular condition, a trend that is only
going to accelerate.
Healthcare marketers take note: as patient sophistica-
tion regarding anywhere health rises, the relative value and
usefulness of basic disease education information declines in
comparison with more nuanced and “advanced” disease edu-
cation. Furthermore, patients will now have multiple sources
to turn to when learning about medical products and proce-
dures – making them less tied to branded messaging. In the
face of these changes, marketing campaigns that simply revolve
around producing a body of product-focused content may not
be the most effective approach.
Follow the data
If the flood of medical data is making traditional marketing
content less effective, that same data can also provide insights
for evolving healthcare marketing. The patient journey is not
static, nor is the data which is generated along that journey. To
effectively reach patients along their journey requires a deep
understanding of what particular triggers and data points mean
– not just from a medical standpoint, but from a personal and
emotional stand point. If the pollen count rises, or blood sugar
levels drop, or BMI stays frustratingly high, all of these data
points have medical implications as well as personal impact.
Effective health communications cannot succeed merely
by transferring facts, but must engage in the narrative story
that each individual patient is experiencing. Obviously medi-
cal writers play a critical role in the development of content
– but does your marketing team have great storytellers who
can empathize and speak with patients on this emotional level?
Does your brand strategy anticipate the ways in which patients
will be gathering their data, sharing their data, and how they
will be progressing along their disease journey in a highly con-
nected world? If your team can learn the patient story and
imagine how critical patient data points will play out, your
brand messaging will become a trusted voice in the conversa-
tion, instead of just another byte of information in the data
flood.
This points to the true value of social media monitoring for
healthcare – not in simply counting the number of mentions
or calculating some type of overall tonality – but in provid-
ing incredible clarity into what real patients are thinking and
feeling in the context of their overall journey. All of the focus
groups in the world cannot match the ongoing stream of social
media insights that can now be monitored.
Timing is everything
The anywhere health environment does not just connect
patients between devices and data; it also connects patients and
products in real-time and over time. Fundamentally, this com-
bination of real-time conversation with long-term social con-
nection might be the biggest challenge that marketing teams
face in today’s anywhere health communications environment
– how to work effectively in a real-time world with patients
and professional customers who do not simply “move on”
after interacting with a brand message.
This challenge is compounded by the regulated nature of
most healthcare communications which limits not just what
can be said but also when it can be said. Internal planning
processes and staffing also conspire against working either in
real-time or with a long-term perspective! As a result, most
brand marketing ends up as a kind of leisurely but not overly
committed “middle-ground” of quarterly or annual commu-
nications flow. The resulting subtext message that gets sent to
patients and HCPs is, “We don’t really want to speak with you
in real-time, and over the long-term everyone on the brand
team is going to be rotated off in a year or two – so we’re not
that interested in speaking with you in the long-term either.”
Ten years ago, in a less connected world, this approach
may have been a workable sort of strategy. Moving forward
though, brand marketers in the healthcare space need to think
very clearly about both their real-time communications voice
and their long-term customer relationship strategy.
Caregiver inclusion is no longer a “Nice to Do”
When a man comes home from a visit to the doctor and
tells his wife that he has a heart condition, or elevated PSA,
or high blood pressure, more often than not the wife will go
online to do further research. In fact, according to a recent
study, up to 91 percent of caregivers conduct their own
research after receiving a healthcare provider recommendation
for their loved one. Furthermore, the same study also found
that more than half of these caregivers use social media sites
like Facebook and Twitter. Pew Internet research has shown
that for chronic and life-threatening conditions, online usage
spikes even higher.
While immediate-level caregivers have always played an
important role in the overall patient journey, the influence of
extended-level caregivers has been amplified in the anywhere
health environment. Now, through social networking sites like
Facebook, “care circles” can easily include friends, distant rela-
tives, and even patients with similar conditions.
TRANSFORMING MARKETING

DTC Perspectives • September 2011 | 43
TRANSFORMING MARKETING
So when immediate family members and these extended
caregivers go online to start researching, what do they find?
When your disease category is typed into Google, do you
know what sites appear on the first page? What about You-
Tube? What is being said about your product on Facebook?
In working with healthcare marketers, it is always surprising
to find brand managers that have not considered these results
from a caregiver perspective. What are the “first impressions”
that your message is making towards caregivers in the online
space? Is your message making any impression at all?! Care-
giver testimonials, decision support tools that spur discussion
between patient and caregiver, and doctor discussion guides
can all be valuable ways to engage your caregiver audience.
End with action
In the anywhere health world, marketing should start with
the patient and ultimately aim towards some type of measur-
able action. The level and type of action will vary depending
on where patients are in their journey; so the type of action
may often be something as simple as clicking on a link or
answering a survey. Other times, the required action might
be simply pointing patients and caregivers to a piece of infor-
mation at the right time and in the right context (based on
your knowledge of the patient journey). Higher level types of
engagement, such as speaking with your physician (or loved
one) about a course of treatment, are built upon these prior
“smaller steps.” Not only should specific types of action be
planned for, but a reliable way to track and measure customer
activity should be developed before the campaign is launched,
allowing for progress to be tracked on a consistent basis, and
corrective changes to be made as certain tactics succeed or fail.
As the technology driving the anywhere health environ-
ment moves forward, patients, caregivers, HCPs and brand
teams will be ever more closely linked in a
sea of real-time data and disease state infor-
mation. Undoubtedly, these changes will
bring tremendous opportunities and chal-
lenges. While it is difficult to predict all of
the ways in which brand marketing will need
to adapt to this new environment, some steps
are already clear:
Move beyond the basics: In light of a
wealth of online health information, brand
teams need to provide more nuanced and
“advanced” disease state information.
Engage on a personal level: As patients
become more intimately aware of their own
condition and progress, brand messaging
needs to understand and speak to the patient
journey on a personal level, not just relay
information.
Listen to what patients are saying: Social
media monitoring provides an unprecedented
view into the patient journey. Use those
insights to understand the patient journey and create
points of meaningful engagement.
Think real-time and long-term: The anywhere health
world is simultaneously real-time and long term, there-
fore brands need to engage both in the real-time con-
versation, as well as set in place infrastructure for ongo-
ing customer relationships. Healthcare marketers have
no choice but to engage.
Master the art of caregiver first impressions: The role
of caregivers should be elevated in brand planning and
in the overall communications mix, with special focus
on how “first impressions” are made online. Caregivers
as immediate family members, as well as those in newly
extended circles of care, are here to stay!
Measure and track the small steps: Measurable actions
should be planned for at the start of each campaign,
with a clear way to measure and track success over time.
Simple small actions can often lead to larger outcomes.
Plan for change: The old days of launching a campaign
and then sitting back and remotely monitoring success
are over. In the active and closely connected world of
anywhere health, brand teams need to stay engaged and
flexible, responding quickly and intelligently to market
changes. DTC
Jim Walker is director of emerging trends at Cadient Group (Cadi-
ent.com), an interactive marketing company emphasizing digital
solutions. An expert in the “anywhere health” model, Walker also
founded the mobile health solutions firm, Anywhere Health (powered
by Cadient Group). Find the latest news and information at Any-
whereHealth.com and on Twitter@AnywhereHealth. Walker can be
reached via e-mail at jim.walker@cadient.com.

44 | DTC Perspectives • September 2011
A new social media platform, Empire Avenue, has emerged that is becoming widely adopted, including by
corporations. Billed as a “social stock market,” pharma companies can discover how effective and valued
their efforts are through their social capital.
by JaNe ChiN, Ph.d.
T
he 2011 DTC National Report (DTC Perspectives,
June/July 2011) referred to Jamie Turner, chief content
officer of the 60 Second Marketer and co-author of
“How to Make Money with Social Media,” who noted that
social media is “currently over-hyped and that it is ultimately
one tool of many.” This leads to a problem of pharmaceutical
companies facing pressure to “engage” via social media. How
does an industry move from decades-old habit of information
dissemination to conversations? More than questions of “how”
and “how much” in social media, a bigger worry for pharma-
ceutical companies is: “how liable?”
Consumers have grown to expect “just in time” responses
to complaints they post on their social networks because com-
panies are constantly monitoring mentions of their brands.
Pharmaceutical companies face an “engagement dilemma”
because current social media trends cannot sustain the “old
way” of communicating a pharmaceutical brand. Yet to stay
within legal and regulatory boundaries and to shift a domi-
nantly negative public perception of their industry, pharma
companies must disclose safety and risk information.
Empire Avenue is a social network game that opened to
the public in July 2010. According to the company’s website
(http://empireavenue.com/about/), Empire Avenue labels
itself as the “Social Stock Market” where players grow their
social capital. Players enter the market with a free member-
ship and choose a ticker and an Index (there are currently #
indices not including sub-indices). As players link their social
networks (Twitter, Facebook, LinkedIn, YouTube, Flickr, and
blogs), their ticker reflects a “share price.” The share price will
increase in value as each social network links up with Empire
Avenue. (For more information about Empire Avenue, see
related sidebar on page 46.)
The “engagement” stage begins when new players are
noticed by existing players. These “investors” can buy shares
in a new player and through word of mouth, alert other play-
ers in their communities about viable new investments. Some
Promises and Perils:
Social Stock Market

DTC Perspectives • September 2011 | 45
investors may check out the new players’ social networks and
engage them on Twitter and Facebook. Players can immedi-
ately participate in interest communities on the site.
Eye on business brands
Empire Avenue launched with an eye for business brands,
basing its value proposition for companies to connect with
individuals deeper than a mere “follow” on Twitter or “like”
in Facebook. The company believes that its platform enables
business brands to reach new and engaged audiences. Com-
panies can create networks of virtual shareholders and access
customers across 150+ countries. At the bottom of the Empire
Avenue “about” page, social stocks of business brands are dis-
played on a rotating basis: AT&T, Oreo (cookies), Swatch,
Toyota, Intel, Dell, Applebees.
Pharma companies interested in using social
media need to identify key opportunities that
are appropriate and feasible to implement
through a social network.
Business brands can generate a lot of buzz upon entry:
when Microsoft (Xbox), BMW, and Rovio (Angry Birds)
signed up, their tickers were announced to a popular private
community group with almost 1,000 members. Within min-
utes, the volume of new share purchases in these business
brands drove sales commissions from 5 percent to 30 percent.
Investors love business brands for the potential virtual wealth
that these brands may generate for shareholders.
“Luxury items” give Empire Avenue immediate monetiza-
tion. Players may spend eaves (e) – the virtual currency to pur-
chase most of the game’s luxury items including watercrafts,
housing, automobiles, airplanes, and seasonal items. But certain
luxury items are available only with cold, hard cash. To buy a
castle, players must spend $100 and in return for 25,000 eaves
earned per week and 4,000 eaves net wealth increase per day.
This concept of premium items enables business brands to
offer not only a presence, but specific products that can benefit
players who commit virtual currency to gain. Microsoft struck
a deal with Empire Avenue to offer an Xbox premium item
under a newly created “electronics” category. Players spend
14,600e to purchase a virtual Xbox 360. This is tied to an
Xbox Fanatic achievement worth 500e (look at this as rebate
or “virtual cash back”) if they buy the Xbox luxury item and
post “Xbox FTW” as a status update on Empire Avenue,
Facebook, or Twitter.
Empire Avenue’s business model capitalizes on free mem-
bership and a commitment to one’s social stock performance
to create stickiness and loyalty to its platform. However
meager its revenue, luxury items allow the company to not
only monetize immediately but to create a means for business
brands to offer virtual products to reinforce their brands to
potential customers.
Opportunities and risks for pharma
Pharma companies interested in using social media need
to identify key opportunities that are appropriate and feasible
to implement through a social network. Pharma companies
have been criticized as not being transparent or engaging with
consumers, and remain faceless entities stereotyped as “pill
pushers” as opposed to contributors to improving standards of
care for patients in healthcare. Social media opportunities for
pharma that may begin to address such issues may include:
SOCIAL STOCK MARKET
Index Ticker Rank Price
Dividends/
Share
Recom-
mended
Share-
holders
FB
Page
Posts
FB Page
Com-
ments
FB
Page
Likes #Tweets
You-
Tube
Activity
Blog
Posts
Technology Nokia VP 143.33 1.21 178 1105 0 3363 10906 368 2 100+
Games:
Console
Xbox
(Microsoft)
VP 127.82 0.27 241 1465 22 7112 42407 25 0 0
Technology Intel VP 124.26 0.8 139 1024 3 381 5911 5 22 22
Technology AT&T VP 113.28 0.78 74 459 16 4411 3088 88 8 8
Cars Ford VP 112.27 0.49 77 647 0 1885 3890 23 1 4
Cars Audi CFO 111.21 0.5 59 510 4 1439 36194 24 0 0
Cars Toyota VP 99.32 0.4 52 381 4 482 1225 17 10 0
The Eaves Oreo (Nabisco) VP 91.28 0.39 28 167 2 3744 22256 25 0 0
Technology Dell VP 87.63 0.33 54 370 8 580 1982 30 0 1
Cars BMW MGR 59.1 0.02 102 521 0 0 0 4 0 0
Week of: July 26, 2011

How Empire Avenue differentiates
E
mpire Avenue differentiated itself from other
social networks by adding a “game layer” to
its social media activity and by aggregating
major social network activities onto its platform.
The allure of Empire Avenue is that aggregate
scores are then converted into a “share price” that
players can track, even if the algorithm behind this
metric remains a mystery to its players. For many
loyal players of Empire Avenue, there is a network
amplification effect that had increased the diversity
of Twitter followers and connections via Facebook
and LinkedIn.
Still, Empire Avenue wants to build its own com-
munities rather than serving as another aggregate
measure like Klout or PeerIndex that also assigns a
number to one’s social media activities: it wants to
keep its players on its site while rewarding players’
social media activities off of the platform. Daily “earn-
ings” are weighed favorably toward Empire Avenue
activities including participation in communities, “lik-
ing” (via clicking a thumbs up icon) on players’ status
updates, and “shout outs” on players’ walls.
These Empire Avenue-driven activities are
combined with aggregate social media activities
and investments (share purchases) by players’
influence, the players’ share price and apparent
social media “value” within the Empire Avenue
walls. Investment even via virtual currency cre-
ates a commitment – however artificial – between
shareholders and their investment. This leads to
some players becoming obsessive over their share
prices. The result? Players’ social media activities
across, within and outside of Empire Avenue often
increase or become more disciplined to sustain
their share “value” via price increase or dividend
yield.
Social media achievement badges based on
milestones in social network activities (includ-
ing number of Twitter mentions and retweets,
number of Facebook “likes” and “comments”)
are unlocked as players attain these within and
outside Empire Avenue’s walls. “Secret achieve-
ments” give an element of mystery and frustration
as players try to unlock these. “Special achieve-
ments” are tied to current events, notably the
“Will and Kate” during the royal wedding and
“Home of the Brave” to celebrate Independence
Day in the United States.
46 | DTC Perspectives • September 2011
1. Announcements of patient adherence initiatives
2. Reminders of product information (such as dosing and
drug interactions)
3. Announcements of disease state educational initiatives
4. Announcements of healthcare reform education for
consumers
5. Directions for reporting adverse events
6. Directions for addressing patient queries about medica-
tion or side effect management
7. Supporting patient advocates/advocacies
8. Identifying consumer and patient influencers
At first glance, Empire Avenue as a platform provides the
means for a social media manager to accomplish tasks in each
of these opportunities. Status updates are also confined to 140
characters, but responses to a player’s “shout-out” (similar to
a response to a status update) are not. Players can create their
own personal communities as long as their share price has
reached 14e, which means pharma companies can potentially
create a moderated community for a particular topic. Com-
munity posts allow longer text messages and recently Empire
Avenue has improved its community format to resemble a
rudimentary message board.
Yet the same features that make Empire Avenue an inter-
esting social network model create risks for pharma compa-
nies. First is the perception of “buy-backs” or investing in
shareholders who have purchased shares of the social stock
for a business brand. Business brands that do not reinvest back
to shareholders are criticized heavily by players: some players
will hold onto the brands’ social stock until it reaches a price
point and “flip” the stock to reinvest profits elsewhere. Play-
ers may then tell others within their communities to sell shares
of the business brand, citing the brand’s lack of engagement.
One automotive business brand was perceived negatively spe-
cifically because it did not reinvest its eaves in players who had
purchased the brand’s social stock.
Thus, there may be an expectation of “buy-back” of players
who have invested in the business brand that pharma companies’
social media managers may not want to, or may not be able to
fulfill. If “buy-back” are fulfilled, the next decision is what the
social media manager will do if a shareholder sells the shares of
the brand’s social stock or buys additional shares of the stock.
Will the manager match the additional buy-back? If the share-
SOCIAL STOCK MARKET

DTC Perspectives • September 2011 | 47
holder sells, will the company hold onto the former sharehold-
er’s social stock or sell? Monitoring of these buy/sell activities
takes up time and does not necessarily increase brand awareness
or accomplish the business brand’s social media objectives.
Next is the participation in communities, interaction
through status-updates or “shout-outs” on shareholders’ walls.
Like any social media channel, the platform is the tool but the
risks fall within what is shared by pharma companies and how
the information is shared. If engagement has been limited by
the companies’ inability to provide proper context (because
of limited text characters per communication), being able to
type longer responses with required safety information may
not eliminate companies’ liability when it comes to regulators’
interpretation of companies’ actions or “intent.”
As it stands, companies that participate in social media
continue to take a limited and primarily responsive approach
to consumer feedback and queries. Participation on Empire
Avenue may not drive a change to the companies’ level of par-
ticipation or engagement. The platform is another social media
tool: it does not and cannot change the risks in interacting
with consumers that pharma companies still face.
Even the choice of ticker symbol – the very first decision
companies must make if they choose to use Empire Avenue
– can be problematic. If the companies choose predictable
tickers like the names of their brands, this is straightforward.
What if a manufacturer of diabetes medication chooses “DIA-
BETES” as its ticker? Can this be interpreted by regulators as
a form of promotion or a type of claim? Can the regulators
view this choice for a brand as claiming to be “the” diabetes
medication instead of “a” diabetes medication? Based on track
record, regulators show what not to do by means of warnings
and letters instead of clarifying what pharma companies can do
on social networks.
Finally, Empire Avenue has real drawbacks as a social net-
working platform: the game layer causes new players to burn
out quickly, especially those who fixate on continuing share
price increases. There have been complaints of spamming and
“content farms” that are not truly reflective of quality interac-
tions, but are rewarded by the platforms tabulation of activi-
ties. In other words, Empire Avenue’s calculation of transac-
tions has encouraged some players to “game the system” in
order to dominate the top slots of indices: CEO, President,
and CFO positions where their profile image are displayed
while other ranks (Vice Presidents, Senior Managers, Employ-
ees) are displayed as lists.
Founders of the platform are taking note of players’ com-
plaints of rewarding the “wrong” behaviors by not differ-
entiating between spam and legitimate actions on the site.
Additionally, players want increased transparency about how
activity-based earnings are calculated. If Empire Avenue bills
its platform as a potential social media training tool (and it
does, by positioning itself as a way of training to integrate
social media interactions across multiple platforms) but guards
its formula for arriving at its social stock price (hence, an indi-
cator of learner’s performance), this renders the tool ineffective
for training.
Based on track record, regulators show what
not to do by means of warnings and letters
instead of clarifying what pharma companies
can do on social networks.
Empire Avenue has the potential for encouraging deeper
social networking relationships within its walls through its
communities and even through player-to-player shout-outs or
messaging system (including shareholder emails that cost eaves
to send). To realize this potential, however, its founders must
improve their reward system to encourage long-term partici-
pation. When multiple “successful” players who dominate lea-
derboards delete their accounts to take a break before “possibly
returning” to the platform (some of them do after a few days,
others after a few weeks), this pattern indicates a game design
that falls short of behaviors congruent with building connec-
tions based on dialog and quality interactions.
Should pharma companies write off Empire Avenue? My
recommendation is for companies to refrain from signing up
their business brands without their social media managers
first becoming very familiar with the platform. Social media
managers assessing Empire Avenue as a social media platform
for their pharma clients should identify not only potential
best practices for meeting opportunity goals (such as the list
of eight opportunities mentioned earlier in this article), but
should establish rules of engagement for this specific platform.
All business brands on Empire Avenue should consider writ-
ing an “investment policy” as part of their “bio” that explains
why the brand is there, how the brand will engage other play-
ers, and how the brand plans to invest as a player on the site,
including policies on buy-backs of shareholders.
Empire Avenue may be questioned as a fad and once upon
a time, Twitter was waved away as a fad; now many pharma
companies are monitoring this fad, if not using it to engage
consumers in a meaningful way. Empire Avenue has created
a niche in the social media space and a unique brand identity
in a relatively short time. This is a social media network to
watch… and one that may be worth waiting for. DTC
Jane Chin, Ph. D. is a healthcare leadership development consultant
and media/content-strategist. She has been blogging and engaging
with Web audiences since 1998 through her private network of blogs.
Additionally, she is an accomplished author and was formerly a colum-
nist for Pharmaceutical Representative magazine. Chin can be reached
via http://about.me/janechin or on Twitter @janechin.
SOCIAL STOCK MARKET

48 | DTC Perspectives • September 2011
GCI Health, a leading healthcare public
relations agency, named Catherine Fal-
cetti as senior vice president, and Julie
Fleisher and Robyn Leventhal as vice
presidents. Falcetti was formerly senior
vice president in healthcare with MS&L, a
communications and engagement agency.
Drawing from her experience leading busi-
ness for Roche, Eli Lilly, Johnson & John-
son, Daiichi Sankyo and Genentech, she
will focus on pharma with specialized, blockbuster and OTC
drugs. Fleisher was most recently vice president of corporate
communications at the public relations firm, Ruder Finn,
where she developed and implemented global PR programs
for Novartis Vaccines meningitis and influenza franchises.
Leventhal was previously a vice president at MS&L, playing
a key role in FDA Advisory Committee meetings and subse-
quent approvals for Genentech’s Actemra and EMD Serono’s
Egrifta.
Saatchi & Saatchi Wellness hired Augusta Duffey as
group creative director. She was most recently an associate
creative director for Euro RSCG, where she led the creative
development on various campaigns for such clients as Scher-
ing-Plough, among others. Pacific Communications added
Catherine Pearson as senior account executive, joining
the Restasis account team. She previously worked at Euro
RSCG Life as an account supervisor.
AbelsonTaylor named Elizabeth Upton Rambach as
vice president, account director; promoted Erin Abbott
from account executive to senior account executive; and
promoted Kiersten Duffey from account coordinator to
account executive. Rambach will continue her focus on the
integration of professional and consumer campaigns for two
infant nutrition products and a major lipid disorder franchise.
Prior to joining the independent healthcare agency, she was
head of the account management department at RTC Rela-
tionship Marketing, overseeing the creation and execution
of DTC programs for five pharmaceutical giants, AARP and
Time Warner Cable. Abbott will be in charge of all digital
and e-marketing initiatives for a pain medication. Duffey will
be working on the launch of a new product for the treatment
of lupus, as well as continuing her work on products in the
areas women’s health and epilepsy.
Ronan Gardiner has been promoted from advertising
director and associate publisher to publisher of Men’s Health
magazine. Rodale Inc. also named Laura Frerer-Schmidt
as publisher of Women’s Health. She was previously associ-
ate publisher of Self magazine. Kevin White was named
publisher of Health magazine. He had been publisher of Real
Simple since 2008. Renee Tulenko, Health vice president,
associate publisher, expanded her role to include strategic
oversight and all day-to-day operations of Health.com.
Good Health Media Rebrands & Grows
Good Health Media is rebranding itself as Precision
Health Media (PHM), sharpening its focus of reaching diag-
nosed audiences.
Citing July data from
comScore, the health
information portal
revealed via news
release that it became “the number one [platform] in total
audience for the online health category at 44.7 million
unique users … [with an] audience reach of 64.9 percent.”
PHM utilizes an analytical technology platform, “Condition
Match,” to pair the most effective and relevant content with
a DTC advertiser’s messaging.
Drumbeat Digital Expands to West Coast
Drumbeat Digital LLC, parent com-
pany of Heartbeat Ideas, has launched
a new integrated marketing company,
Heartbeat West. Based in Los Ange-
les, Heartbeat West is a privately held,
full service agency providing ideas and
innovation in the emerging market-
ing environment to clients on the
west coast. The company’s proprietary GRADE™ toolset
rigorously mines competitive and audience insights from
the complexity of the digital landscape, while the agency’s
versatile engagement process flexes to meet the needs of both
traditional and digital environments.
Laura Frerer-Schmidt Kevin WhiteAugusta Duffey
ON THE MOVE

ADVERTISING INDEX & RESOURCE CENTER
Company
Page
Website Phone Contact Email
Beacon Healthcare
Communications
5 beaconhc.com 908-781-2600 Adrienne Lee alee@beaconhc.com
ContextMedia 9 contextmediainc.com 847-912-9612 Shradha Agarwal shradha.a@contextmediainc.com
Epsilon 55 Epsilontargeting.com 1-800-603-4555 Info@epsilontargeting.com
GSW Worldwide 56 gsw-w.com 614-543-6951 Greg Henderson greg.henderson@gsw-w.com
Parade Magazine 2 parade.com 212-450-7141
Remedy Health Media 15 Remedyhealthmedia.com 212-695-5581 Jim Curtis Jcurtis@remedyhealthmedia.com
SDI 11 sdihealth.com 1-800-982-5613 Melissa Leonhauser Mleonhauser@sdihealth.com
SSI 7 surveysampling.com 203-567-7220 Chris DeAngelis
Chris_DeAngelis@surveysampling.com
Jane Chin, Ph. D. is a healthcare leadership develop-
ment consultant and media/content-strategist. She has
been blogging and engaging with Web audiences since
1998 through her private network of blogs. Additional-
ly, she is an accomplished author and was formerly a col-
umnist for Pharmaceutical Representative magazine.
Chin can be reached via http://about.me/janechin or on Twitter @
janechin. Turn to page 44 to read her article.
Nami Choe is partner, senior director, consulting with
Ogilvy Healthworld. Ogilvy Healthworld is an innova-
tive full service marketing agency and a part of Ogilvy
CommonHealth Worldwide. Choe can be reached by
telephone at 212-237-4789 or by e-mail at Nami.
Choe@ogilvy.com. To read her article, turn to page 17.
Qi Jiang is vice president of marketing science for
Phoenix Healthcare’s syndicated business. Phoenix
Healthcare is a business unit within Phoenix Marketing
International, the nation’s 28th largest marketing research
firm. The Healthcare unit tracks over 25 percent of all
DTC spending in pharmaceuticals. Jiang can be contact-
ed via e-mail at Qi.Jiang@Phoenixmi.com. To read the article she co-
authored with colleague Doug Zabor, turn to page 26.
As chief creative officer, Bruce Rooke provides strategic
leadership for GSW Worldwide’s creative team. His
responsibilities include establishing and implementing
standards for creative work and ensuring that strategic,
creative, and branding processes are used consistently
across the agency. Rooke can be reached by e-mail at
brooke@gsw-w.com. Turn to page 20 to read his article.
Todd Steffes is a vice president at FICO, and the lead-
er of the company’s health care business unit. For more
information on the FICO Medication Adherence Score,
please visit www.fico.com/adherence. Steffes can be
reached by e-mail at toddsteffes@fico.com. To read his
article, turn to page 22.
Jim Walker is director of emerging trends at
Cadient Group (Cadient.com), an interactive
marketing company emphasizing digital solu-
tions. An expert in the “anywhere health”
model, Walker also founded the mobile
health solutions firm, Anywhere Health
(powered by Cadient Group). Find the latest news and
information at AnywhereHealth.com and on Twitter @
AnywhereHealth. Walker can be reached via e-mail at jim.
walker@cadient.com. Turn to page 41 to read his article.
Tanayia Washington is insights and ana-
lytics manager for digital media services
firm CONTEXTWEB. CONTEXTWEB
is a real-time contextual advertising solu-
tions provider for online advertising and
publishing. Washington can be reached by
e-mail at twashington@contextweb.com. To read her
article, turn to page 32.
Louis Winokur is currently the director of
analytics at DKI. With over 15 years of mar-
keting experience across analytics, client con-
sulting and product development, Winokur
has worked extensively on consumer segmen-
tation and analysis of purchase patterns across
various products and categories. He can be contacted via
e-mail at lwinokur@dkidirect.com. Turn to page 36 to
read his article.
J. Douglas Zabor is executive vice presi-
dent of Phoenix Healthcare’s syndicated stud-
ies. Phoenix Healthcare is a business unit
within Phoenix Marketing International, the
nation’s 28th largest marketing research firm.
The Healthcare unit tracks over 25 percent of
all DTC spending in pharmaceuticals. Zabor can be
reached by e-mail at Doug.Zabor@Phoenixmi.com. Turn
to page 26 to read the article he co-authored with col-
league Qi Jiang.
CONTRIBUTORS
DTC Perspectives • September 2011 | 49

ON THE HILL
by Jim davidSoN
J
ust hours before the August 2nd
deadline, Congress and the Presi-
dent reached an agreement to raise
the nation’s debt limit up to $2.4 trillion
in two stages. Passing with a 269 to 161
vote, the federal government can con-
tinue to borrow until 2013. However,
neither party is particularly satisfied
with the plan. Our government’s fail-
ure comes in spite of numerous com-
missions, negotiations, and yes, even
gangs that have formed, disintegrated,
and revived themselves over the past
half-year in multiple attempts to resolve
this issue – at least until the next time
Washington has to statutorily raise the
debt ceiling to accommodate its spend-
ing habits.
The Congressional Research Ser-
vice reports the Congress has voted to
increase the debt limit 74 times since
1962. The last 10 votes occurred in the past decade alone.
We are far from being in the clear; Washington desperately
needs to rethink the way it conducts business. It is likely that
the best we can manage may be with the $2.4 trillion dol-
lars in cuts – of which $900 billion is immediate – and some
maneuvering of debts to keep us from default.
The debt issue poses few problems unique to the DTC
industry apart from the obvious fiscal catastrophe that would
hit every market if we fail. The reality is that the only sensi-
ble way to get out of this hole is to implement a debt reduc-
tion plan that both reforms spending and entitlements and
reevaluates our entire tax code. Republicans have embraced
the adage that “Washington doesn’t have a revenue problem,
it has a spending problem.” To a certain extent, they’re right.
The government had netted $814.9 billion in individual
taxes as of July 2011 and $134.3 billion in corporate taxes
– increases of 24.3 percent and 1 percent over the previous
year, respectively. Yet we still spent more than 1.5 times the
amount we have taken in during this entire fiscal year. Even
Democratic Senator and Budget Chairman Kent Conrad (D
– N.D.) recognized the state we’re in on a recent national
news show interview: “If you look at our spending, it’s the
highest it’s been as a share of our economy in 60 years, rev-
enue is the lowest it’s been as a share of our economy in 60
years, [and] so we’re going to have to work both sides of the
equation.”
The trick is that while everyone
agrees that we must reassess our tax
policy, you cannot do that without
opening up the Tax Code and evaluat-
ing every credit, deduction, and loop-
hole against sound tax policy standards.
That puts everything on the table and,
by extension, at risk. We have wit-
nessed this threat many times before. It
is important to note that the deduction
of the cost of advertising as an ordi-
nary and necessary business expense
has been established tax policy since
the Tax Code was enacted in 1913. It
never has been treated as a tax expen-
diture or as a preference item.
The larger issue that doesn’t receive
nearly as much attention is the burden
that this fiscal uncertainty places on
corporations and their business plans.
Ask CEOs of any company about their
number one business concern and their likely response will
focus on the government’s ambiguity about how to fix the
tax code, or when. Businesses large and small are increasingly
challenged about how to budget for raw materials, supplies,
new equipment, employees, and benefit plans – an uncer-
tainty that has to contribute to the stagnation in growth in
this country at a time when our anticipated recovery is on
the rocks.
Advertising, after all, does not exist in a bubble. As DTC
executives increasingly work to reexamine their models and
the returns on investment from DTC spending, decisions
made in Washington or the absence of sound decisions con-
tribute to perpetuating a climate of instability. A resolution to
the debate over crucial deficit and our mounting long-term
debt would be an important first step toward returning us to
stronger economic growth for our industry and potentially
provide a strong impetus to renew marketing programs that
will help stimulate sales and a brand in the current stagnation.
Jim Davidson is an attorney and founder of the public policy firm
Davidson & Company. He currently chairs the Public Policy Group
at the Washington law firm of Polsinelli Shughart PC, and he
has been actively engaged in supporting the advertising industry on
Capitol Hill for almost 20 years. In October 2008, Davidson was
inducted into our DTC Hall of Fame. He can be reached by e-mail
at jhd@davidsondc.com.
The Debt Ceiling is Just the
Tip of the Iceberg
While an agreement was reached regarding the debt ceiling, uncertainty still looms. Aside from the
significant risk of defaulting, without reforming spending and entitlements, we are far from being in the
clear. A long-term resolution would be an important first step toward returning us to stronger economic
growth for our industry.
50 | DTC Perspectives • September 2011

Enter the 2012 DTC Awards
Plan now to submit your entry to the DTC National Advertising Awards and nominate
a colleague from a pharmaceutical company for the Top 25 DTC Marketers of the Year.
Entries are free and simple. Visit www.dtcperspectives.com for full details.
2012 AWARDS
Don’t Miss Your Chance to enter the 2012 DTC Awards
Associated with the DTC National Conference
April 10-12, 2012 at the JW Marriott in Washington, DC
Visit www.dtcperspectives.com for full details.
advertising awards
Top 25 DTC MarketersTop 25 DTC MarketersTop 25 DTC Marketers
Winners from the 2011 Advertising Awards
The DTC Advertising Awards are designed
to recognize communication excellence in
a fi eld with multiple constituencies, varying
needs and signifi cant communication
challenges. Entries will be judged by a panel
of independent industry market research
experts. Gold, Silver and Bronze awards will
be presented in each category at the 2012
DTC National Conference.
Top
DTC Marketers
from the
2011 Class
The Top 25 DTC Marketers of the Year are selected for their leadership and infl uence in DTC
marketing. This award acknowledges the contributions of elite marketers from pharmaceutical
companies working toward the advancement of patient outcomes via direct-to-consumer (DTC)
pharmaceutical education and marketing.

W
ho wants to live to 100? Is today’s 70 the new 50?
Will baby boomers live active lives until their 90’s?
Will the children of baby boomers live routinely
to 90? Do we really want to look forward to living 100 years?
These are the questions Susan Jacoby explores in her new
book Never Say Die. Based on the subtitle “The Myth and
Marketing of The New Old Age” one gets the sense that Ms.
Jacoby is not all that optimistic. Jacoby is a veteran writer and
reporter for numerous newspapers and magazines.
We as a society are barraged with cosmetics, foods, supple-
ments, books, procedures and exercise equipment that prom-
ises extended youth. While it is clear that the 50-plus age
looks, dresses and acts younger than our grandparents did, the
questions Jacoby answers are deeper. Is it really possible to
have an active old age that makes living until our 90’s an excit-
ing prospect?
The short answer is no. Despite the claims that we all can
be running on the beach well into our senior years, with
an active sex life, pesky diseases under control, eating out
at trendy restaurants and traveling the world is a myth, says
Jacoby.
Never Say Die is an attempt to look at the facts of aging,
rather than the marketing hype of purveyors of fountain of
youth products. Jacoby concludes that living into your 90’s is
not that much more likely and even if one reaches that age,
it is likely the life you will lead is one of frequent discomfort,
dependence and likely decline in cognition. Though, it is true
that people in their 60’s likely live a more active life because
of modern medicine and a recognition by society that they
can still be fashionable and sexy. We see Jane Fonda, Raquel
Welch, and Christie Brinkley still looking sexy into their later
years. We all remember how women of that age were expect-
ed to wear appropriate clothes and hair. Grandma shoes and
floral blouses were the norm.
Jacoby makes the case that once we reach our 80’s we are
likely to get sicker and more dependent on someone else to
take care of our daily needs. Marketers like to show the young
old using their products. Jacoby cites erectile dysfunction ads
where the actors are all in the late 40’s or early 50’s. Market-
ers know that showing real old people is not attractive. The
marketing myth is that we can all live active lives like never
before. There is no reason to age cites the longevity industry.
Age is a state of mind
and is controllable with
proper diet, exercise,
and a little help from a
pill or two.
Yet, Jacoby says that 50 percent
of people who live to 85 will develop senility. Most will not
have the financial resources to survive without government or
family aid. Most will develop vision problems, bone weaken-
ing, arthritis, high blood pressure and other serious conditions.
Jacoby traces the history of aging in an interesting chapter
of how we treated old people historically. Of course that was
easier a hundred years ago when their fewer of them. Most did
not reach their 60’s so accommodating the elderly, both socially
and financially was easier. Yet, says Jacoby, we did not treat old
people too well then either. They frequently had to beg to sur-
vive, and their last years were spent alone and in pain. She says
the idea that their children always took them in was a myth.
Jacoby is at her best when she describes the financial health
of the elderly. Most outlive their savings, especially post-reces-
sion where investments hurt dramatically. Since most peoples’
wealth is in their house value, that decline is severe for middle
income people. Jacoby also describes how we artificially
extend life where quality is gone. This is bankrupting our
health system as well as denying the elderly a dignified death.
Never Say Die is not an optimistic book. No one will be
uplifted by it. On the other hand it is a sobering reminder that
we cannot, at least yet, make old age a seamless transition from
youth. It is inevitably going to be a period of decline and not
loads of fun. Jacoby is not arguing that life extension is not
good, just that we are being conned by longevity gurus that
we can spit in the eye of old age and act whatever mental age
we want. Yes, 70 may be the new 50, but 90 is probably the
old 87.
Robert Ehrlich, chairman and chief executive of DTC Perspec-
tives Inc., regularly reviews books about the pharmaceutical industry,
marketing and advertising for DTC Perspectives magazine. He
also writes a weekly e-newsletter providing insights on pharmaceuti-
cal marketing trends. To subscribe to this FREE weekly analysis,
sign up at the website, www.DTCPerspectives.com. Ehrlich can be
reached by e-mail at Bob@DTCPerspectives.com.
Never Say Die
The Myth and Marketing of The New Old Age
By Susan Jacoby
Published by Pantheon Books • 2011 • 332 pages
revieWed by roberT ehrliCh
ON BOOKS
52 | DTC Perspectives • September 2011

Marketing Diabetes
Prevention and Awareness
June 6-7, 2012
Intercontinental Hotel
Buckhead
Atlanta, GA
www.mdpaconference.com
For more information, please contact Scott Ehrlich
at 770-559-0702 or scott@mdpaconference.com
Follow us on Twitter for updates,
discount offers, and more:
@MDPAConference

O
bamacare or Nobama care? When
will we know? Appeals courts
have ruled on the legislation both
ways. The Supreme Court will tell us some-
time next year, we hope, whether this is the
law of the land or part or all of it is uncon-
stitutional. It does not matter what the par-
tisan spin doctors tell us on cable television
about who is right. It only matters what the
Supreme Court says in a likely 5-4 ruling.
If the individual mandate is ruled uncon-
stitutional, then how we will fund Obam-
acare? Underpinning the new law is all
of these healthy people buying insurance
to subsidize the
uninsured. With-
out them the
program falls apart financially.
Our hope is that we get a
chance to start over using more
free market measures. We sup-
port several free market ideas that
should lower cost overall while
broadening access. First, consum-
ers need to be allowed to buy
insurance across state lines to get
the best deal. Second, we must encourage and grow the use
of less costly medical personnel to diagnose and treat com-
mon illnesses. These can be more use of nurses, physician
assistants, or a new class of medical diagnosticians with less
training and cost. Third, we would like to see tort reform to
reduce excessive cover-your-butt-testing.
Fourth, it is important to better educate
and train consumers to know what things
cost and put some personal skin in the game
with their own money. Fifth, we can utilize
our vast retail network to expand speedy
clinics and reduce use of emergency rooms.
Finally, we need to stop paying extraor-
dinary amounts of money to keep people
alive that final week or two when there is
no hope of recovery or any quality of life.
Obamacare is not realistic in requir-
ing high quality plans for all and telling us
somehow it will cost less. That is really just
disguised price controls. All we will end
up with is mediocre care with shortages of
providers and consequently long waits for
service. We would much rather see some genuine free mar-
ket principles applied before we surrender to government
run health. We are not advocating the status quo. We need
change we really can believe in and Obamacare is not cred-
ible.
Of course the longer we wait for that one deciding
judge, we have significant uncertainty for a $2.3 trillion part
of our economy. This is delaying investment in the sec-
tor and reducing, not increasing, employment. Would any
healthcare entrepreneur put serious new capital at risk not
knowing the potential ground rules? We doubt it; so what
is the Supreme Court waiting for? We need some supreme
pragmatism here, not delay while 300 million lives are put
on healthcare hold.
While we await a ruling on the constitutionality of Obamacare, millions of people are being
left in limbo. The reformed healthcare system should utilize more free market measures before
conceding to a government run structure.
EDITORIAL
The Uncertainty of
Healthcare Continues
We would much
rather see some
genuine free market
principles applied
before we surrender
to government run
health.
?
54 | DTC Perspectives • September 2011

Meet Elizabeth
She is actively living with Rheumatoid
Arthritis.
We also know she is:
• Retired
• Lives in Houston, Texas
• Takes ber supplements
• Motrin is her usual pain reliever
epsilontargeting.com
1.800.603.4555
info@epsilontargeting.com
Copyright © 2011 Epsilon Data Management, LLC. All rights reserved.
The data that matters.
Epsilon Targeting — your prescription for marketing success!
For the RX marketer, choosing the right data provider is critical. That’s why major pharmaceutical
and OTC brand marketers depend on Epsilon Targeting for the data that matters most. With the
industry’s most comprehensive source for hard-to-nd ailment and health data, we can provide
deep insight into your best prospects to drive acquisition and adherence.
Epsilon Targeting has
650,000 Rheumatoid Arthritis
sufferers in our database.

Action is worth
a thousand ads
@GSW
details at
thewellatgsw.com
To introduce ourselves, we’d like to offer
a free Brand Well Check. Our proprietary
assessment of your brand’s potential to bring
wellness value.
The Well @GSW offers depth in health and wellness:
Counsel - New ideas to bring value beyond therapy.
Content - Creative brand engagement.
Communications - DTC with a more authentic view.
49611_nchmar_action_ad_fa.indd 1 8/11/11 4:25 PM